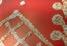

healthy hints from our experts


singer layla havana is lending her voice to the coast’s youth mental wellness festival

827 SEPTEMBER 26, 2024




















yle begins at $525,000...

building can now commence within our final residential land release.
Stage III of our Lancelin Precinct offers the last residential homesites for sale within Sunshine Cove. As a result, many allotments were secured off plan, prior to title release. Fortunately we still have a good selection of breathtaking waterfront land and dry allotments to choose from. Best take a look today.
Sales office open Monday to Friday, to make an appointment please call 5443 2766. Average Waterfront $957,000. Average Dry/Park $637,000. Prices are subject to availability and are subject to change without notice.

Did you know one in four Australians aged 16 and over have experienced child sexual abuse (CSA)? Sobering figures indeed.
It’s a deeply sensitive and crucial issue that demands our attention, empathy and understanding. And, although it can be a distressing subject to talk about, without open conversations and awareness, nothing will change.
In this edition, we share a feature story that addresses the experience of CSA survivors and highlights the strength of the human spirit to rise up and help others by speaking their truth.
Journalist Lucinda Dean bravely shares her own personal journey, and we meet a CSA survivor and her mother who are creating positive change for child and youth victims of sexual abuse in Australia through their charity.
This story is not just about pain and trauma; it’s also about resilience, advocacy and the power of community.
We hope it sparks important conversations, inspires action towards prevention, and helps foster awareness to drive change.
Thank you to those who were brave enough to share their stories with My Weekly Preview
Ingrid Nelson inelson@myweeklypreview.com.au


festival tunes up with $2 million in
the event.


Bakery relocates after outgrowing original home – A bakery that began as a hobby during COVID has moved to new premises after it outgrew its original base.

All aboard? How locals have responded to 50c fares – Many Sunshine Coast locals and visitors have been making the most of the

Email editorial@myweeklypreview.com.au | sales@ myweeklypreview.com.au | PO Box 6362, Maroochydore BC, Qld 4558. PHONE: 5444 0152, DISTRIBUTION: distribution@myweeklypreview.com.au. PUBLISHERS: Anar Higgins, Darryl Olson, Michael Kramer, Noel Olson. For the publishers’ statement, see the “terms of use” tab at myweeklypreview.com.au.





Win a family pass Jets Day is on Saturday, September 28 at the Queensland Air Museum. Listen to the tour guides as they give talks on the introduction and progression of jet aircraft into the military, from WWII, through the Cold War years, Vietnam and to the present day. View the many jet engines on display.
For your chance to win, visit our website: myweeklypreview.com.au.

Do you have a story to share? Let journalist Caitlin Zerafa know about it. Email your story to localnews@myweekly preview.com.au FOR MORE FREE LOCAL NEWS VISIT SUNSHINECOASTNEWS.COM.AU
















Not sure if there is a way to save water and have a happy lawn? Read on for Unitywater’s top tips for spring gardening and water-saving.
Unitywater has shared its top 10 water-wise tips to help spring gardeners prepare their yards to stay cool, green and tidy as the weather warms up.
With warmer than usual temperatures predicted for southeast Queensland over the coming months, the water utility recommends adopting simple yard care habits and gardening methods that can help your garden thrive with less water.
Unitywater executive manager strategic engagement Joshua Zugajev says there are small changes that can be made
to maximise time outdoors.
“We’re fortunate to live in a warm climate and it’s important we’re able to get out and enjoy it while being wise about the way we use our most precious natural resource – water,” Mr Zugajev says.
“Around 40 per cent of household water is used up through outdoor activities like cleaning and gardening, so it’s important we remain mindful of this while we’re outdoors,” he says.
“Get creative. Why not bath the kids while they’re in their splash pools, then use the water to give your garden a drink?”
1. Water the garden at cooler times. It’s best to do your watering before 8am or after 5pm when the weather is cooler. Watering during hot and windy times of the day leads to more evaporation. Did you know? Lawns under our climate all turn a little browner when it’s hotter, and watering twice a week is enough to keep your yard hydrated. To keep grass greener, allow it to grow to at least five centimetres long.
2. Cover your pool. Did you know that pool covers aren’t just for keeping things out? They also keep your water in as they reduce evaporation.
Did you know? A tarp safely held down at each corner with a weighted item like a rock or sandbag is a cheap and effective way to achieve the same outcome if you don’t have a fitted cover.
3. Choose drought-tolerant plants. If you’re putting your green thumb to use, opt for drought-tolerant lawn species and plants like natives and succulents that require less frequent watering. Did you know? Your local nursery can help you choose the right plants for your garden.
4. Check the pool for leaks. Avoid higher water bills from topping your pool up too often by regularly checking your pool for leaks.
Did you know? A simple way to check for leaks is to turn your pool equipment off and mark where the water level is. Leave it for 24 hours, and if the water level has dropped, you might have a leak. For more information on ways to check, head to unitywater.com/waterwise-outdoor.
5. Use mulch. You want to aim for a depth of about five to 10 centimetres. Investing in good-quality mulch like sugar cane, wood chips, gravel and stone can help retain moisture and
reduce water evaporation.
Did you know? Mulching can also help control weed growth.
6. Make use of greywater. Greywater is the term given to water used in the bath, shower, sink and laundry.
Did you know? Greywater can be reused in the garden or on the lawn. For tips on how to use greywater safely, visit unitywater. com/greywater.
7. Pull out weeds. Those pesky weeds compete with your lawn and plants for moisture and nutrients.
Did you know? Getting rid of weeds will keep your garden hydrated for longer.
8. Sweep your driveway. To save on water usage, use a broom instead of a hose to clean your driveway and other outdoor areas like patios and footpaths.
Did you know? A hose uses 10-14 litres of water per minute.
9. Avoid planting near wastewater lines. Some tree roots can penetrate water and wastewater pipes, causing them to become blocked or broken. This can lead to an overflow on your property, or a concealed leak that can result in a higher than usual water bill.
Did you know? You can check where water and wastewater pipes are located on your property and see our planting guide at unitywater.com/think-before-you-plant.
10. Use controlled watering tools. Use a handheld trigger nozzle on the end of your hose for everyday watering or a drip irrigation system for larger gardens and lawns.
Did you know? Watering tools can reduce water usage by 30-50 per cent each time.
There you have it, 10 great tips to help reduce your water usage this season. For more residential water-saving tips, visit the Unitywater website at unitywater. com/water-wise.











Cows have best friends and get stressed when separated. Research shows that cows form strong social bonds with certain herd members, much like humans. When they are with their preferred companion, their heart rates tend to be lower, indicating a calmer state. However, when separated, they exhibit signs of anxiety. This quirky fact reveals the emotional depth of animals and highlights the complexity of their social structures and wellbeing.



“Nobody made a greater mistake than he who did nothing because he could only do a little.”
– Edmund Burke, Philosopher

A strawberry is not actually a berry and yet a banana is. In botanical terms, a berry is a fruit that develops from a single flower with one ovary, containing seeds within its flesh. Strawberries, however, develop from a flower with multiple ovaries and bear seeds on their exterior, making them an aggregate fruit. Bananas, meanwhile, fit the true berry criteria.

It is said that on average we spend six months of life waiting for red traffic lights to turn green.

80%
More than 80 per cent of the world’s oxygen is produced by oceanic phytoplankton, not trees.

In Egypt in 2015, 3000-year-old honey was discovered by archaeologists. It was edible!
In 1856, Australia became the first country in the world to implement the secret ballot in elections, known as the ‘Australian ballot’. Before this, voting was conducted publicly, often leading to intimidation and corruption. The new system allowed voters to mark their choices privately, significantly reducing undue influence and bribery. The initiative set the standard for democratic elections globally, emphasising fairness and privacy.






1810 – The Swedish Act of Succession, also known as the 1810 Act of Succession is adopted by the Riksdag of the Estates. This act is part of the Swedish Constitution and regulates the succession of the royal family.
1914 – The Federal Trade Commission (FTC), an independent government agency in the US, responsible for consumer and market protection is established by the Federal Trade Commission Act on this day.
1917 – The Battle of Polygon Wood began. Fought during World War I between the British and Australian troops and German Army near Ypres in Belgium, the battle ended in an Allied victory.
1959 – Typhoon Vera hits Japan. The category five typhoon is thought to be the strongest typhoon to impact the island country in recorded history. The resulting rain and landslides caused the deaths of around 5000 people.
A formal word often used to describe an intermediate state, phase, or condition – the in-between; barely perceptible or barely capable of eliciting a response.



Get a sneak peek of the lifestyle you could enjoy at Sunset Palms’ Open Home event. With limited villas in stage 3 remaining and ready to move into this year, come and explore the
Grab a quick bite from the food truck
Delight the kids with colourful balloon creations
Tour and inspect our display villas
Chat with our friendly team Enjoy live entertainment







Writer Lucinda Dean bravely shares her story as invaluable charity No More Fake Smiles marks its fifth year of helping child sexual abuse survivors. Warning, this story contains content that may distress some readers.

If you visited Sunshine Plaza and saw 200 women shopping, could you detect which 22 of them were sexually abused before age 15?
Of those survivors, some might choose to wear a mask of secrecy while others might choose to tell someone about their past.
The reasons why a survivor reports or does not are as complex as the individual themselves. But what we do know is shame is a powerful silencer.
On average, it takes 23.9 years for a survivor to make a disclosure.
For me, it took 36 years to tell my family. I’m now 51. This is the first time I’m publicly sharing my story. It’s my hope that in sharing our stories, we can de-stigmatise the shame. I acknowledge too that sharing is not for everyone, and there is no judgement around that.

Nearly a decade ago, I was pegging clothes on the line when I heard a little girl pleading loudly. She was frightened and in distress.
This cry plunged my mind back 30 years with force. The words and pain; echoing a school friend’s suffering from a long time ago.
I quickly scanned the neighbouring apartments to see where the voice was coming from. Her cry for help rang in my ears. My impulse was to call the police, but I felt ridiculous not being able to pinpoint where the little girl was. I went back inside, shook my head, and said to myself, ‘that was weird’.
But the little girl’s plaintive cries continued to haunt me for days, weeks afterwards. Finally I came to the realisation that the voice I heard was in fact inside my head.

It was my first ‘breakthrough’ memory although I didn’t know that’s what it was at the time. I just thought I was going crazy.
Years later, these PTSD flashbacks began to build in intensity, crashing over me in waves. Snippets of memory surfaced like jumbled scenes from an old film reel, but I saw enough to know both my friend and I had been child victims at the hands of a stranger.
Prior to starting therapy, I had a history of engaging with certain older men in dysfunctional ways. And in these trysts, I always came off second best.

have a much healthier relationship with myself and others.
I feel my story highlights the farreaching negative consequences of child sexual abuse (CSA) on adult lives.
No More Fake Smiles is a Coast charity working to eradicate the stigma surrounding CSA, enhance protection and respect for affected children and advocate for systemic changes to the law and court proceedings.
The nationally recognised charity was founded in 2019 by survivor Annie Jones and her mother, Tracey Morris, to provide a safe and supportive environment for children and youths aged 0-24 to heal from the trauma of sexual abuse.
Annie says one of the biggest misconceptions in society is ‘stranger danger’. According to the Australian Bureau of Statistics, 84 per cent of child sexual abuse victims know their perpetrator.
Annie was first raped by her stepfather at the age of 12. The attacks continued for three years. The now 24-year-old says at age 12 she thought what was happening was “normal” and in her child-mind she believed that others at home, her mum and three siblings, knew what was going on.
By 14, when the assaults increased in frequency, Annie began to understand that it was “wrong” but felt powerless to stop it. As a child, she felt it was an issue she had to deal with on her own and, as a result, learned to wear a fake smile mask as a coping mechanism.
“When we would go for family events like Christmas, everyone would be laughing with my stepdad and smiling and I would be thinking, ‘this is so weird, I hate him’, but I knew that if I acted like I didn’t like him, or made a comment about him not being nice, it would only end up being worse for me.”
When Annie was 15, the truth spilled out one night when her stepdad accused her of being promiscuous when she came home sporting a hickey. Annie says she took a deep breath and then ventured: “There’s something else”, but stopped herself. Annie’s mum, Tracey, said, “No, what’s going on? You need to tell me”.
I know now that it was a misguided attempt to quench a need for personal power. I now
“She (mum) sensed that something was wrong, and then I said: ‘It’s nothing more than what you’ve ever done to me, Dad’. He instantly got up and started pacing and accused me of lying. The rest of the night is a blur.”


So far this year, No More Fake Smiles has provided 315 hours of comprehensive support to numerous children and youth aged four to 24, ensuring they have access to trauma-informed, personalised therapy options and specialised support care before, during and after criminal proceedings.
To date, they have supported youth clients in Maroochydore, Brisbane and Gympie Courts, providing crucial assistance throughout their legal proceedings.
Additionally, Annie and Tracey supported the Justice Shouldn’t Hurt campaign, which successfully pushed the New South Wales Government to pledge $64.3 million over four years to expand the Child Sexual Offence Evidence Program.
Their work, which is solely funded by generous donations from the community, has been recognised by the Queensland Police Service as an official referral service for the Brisbane Local Area Command. nomorefakesmiles.com.au
Tracey believed her daughter and supported Annie through a lengthy judicial ordeal, which saw the man jailed for 17 years, with a non-parole period of 11 years. But after the sentencing, Annie says she “fell apart as a person”.

“I just believed that I had done everything that I was set to do in this world – I graduated Year 12, I’d got into uni, but I couldn’t keep going. I just thought it was impossible, and I honestly couldn’t see a future for myself, so I ended up in the Sunshine Coast University Hospital’s (SCUH) psychiatric ward as an involuntary in-patient because I made an attempt on my life,” she says.
Adult child sexual abuse survivors are two-and-a-half times more likely than the general population to have suicide ideation. They’re four times greater to make suicide plans and the likelihood of attempting suicide is three-and-a-half times more likely.
While in SCUH, Annie realised she wasn’t alone in her experience of CSA. She describes this epiphany as “life-changing”.
“I was just overwhelmed with this feeling of needing to not only talk about it but to create change and offer help.”
No More Fake Smiles was born of the horrific adversity Annie faced in her young life. Now, in addition to working for the charity and as a teacher’s aide, Annie is undertaking a degree in Social Science/ Psychology and getting married next year.
She radiates positivity and with boundaries firmly in place, no longer has a need to wear her fake smile mask.
“My journey of survival drives me every
Secrecy is vital for abuse to continue and it only serves the perpetrator. Trauma-informed psychologist Dr Alanda Thompson shares her insights into the impacts of child sexual abuse on adult survivors.
• Children who are abused feel ashamed as they know what is happening is wrong and yet they are told by allpowerful adults that it is their fault. As adults, this shame is re-triggered by interpersonal rejection. People who have been sexually abused as children have had a trauma happen to them, and this trauma has been caused by people, not by a hurricane or a car accident. So, people become the feared presence. Yet, as mammals we all need closeness to other mammals, so there is this terrible paradox of needing to get close and yet fearing that very closeness. Fear of rejection can run the lives of survivors because being rejected triggers the shame of feeling fundamentally flawed and different from other people.
• To be sexually abused you have to be told to keep secret awful things that happen to you, to ignore feelings and alarm bells. This process of denying and second guessing the self, makes the grown adult very vulnerable to people who enjoy using others and exploiting their vulnerability. It’s common for people who have been
day to help others find their strength and start their healing process,” Annie says.
“By sharing my story, I hope to take away the shame and hurt for others.
“I know through our charity being a voice, light and space for healing, this pain will be minimised. The impact our charity has made on the lives of the individuals and families we have supported is something money can’t buy.”
You can support No More Fake Smiles


sexually abused as children to become victims of domestic violence.
• The notion of women being crazy is a historical furphy. Thankfully we now have a trauma-informed approach to therapy, which sees the seemingly crazy behaviours of survivors conceptualised as survival responses. For instance, it’s all very well to tell people to be assertive but if that would have resulted in a catastrophic backlash from an abuser that would be a completely unhelpful thing to do. This makes sense of conflict avoidance and people pleasing, which we often see in survivors. If you are a young person who needs help, phone Kids Helpline on 1800 55 1800. If you or someone you know is struggling with thoughts of suicide or self-harm, please contact Lifeline on 13 11 14.
and celebrate Mental Health Week at the fifth birthday celebration on October 5 from 5.30pm at the Bli Bli Hotel.
The event features a cocktail on arrival, two-course dinner and live entertainment. Tickets are $129 and available at nomorefakesmiles.com. au/5th-birthday-celebration.
If you can’t attend, you can contribute to the charity’s ongoing support services with a tax-deductible donation. Visit

Members and guests enjoyed a delicious breakfast at the Maroochydore Surf Club recently while listening to the insights of the 2024 Sunshine Coast Business Women’s Network Award winners. It was an opportunity for guests to connect with these leading local businesswomen and learn about their journey to success.


















The Montville Chamber of Commerce enjoyed a delicious feast at Flaxton Gardens for their recent annual general meeting. Mayor Rosanna Natoli was the special guest speaker and the event was emceed by Andrew Fairbairn from Visit Sunshine Coast.
















































































More than 239 entries were received for this year’s Sunshine Coast Business Awards, with the finalists announced this week.
One-hundred and thirty finalists have been named for the annual Sunshine Coast Business Awards.
Finalists were selected from 239 entries across 17 categories, with an increase in the number of businesses participating for the first time.
Sunshine Coast Business Awards chair Jennifer Swaine says local enterprises are keen to get involved.
“Congratulations to all of this year’s finalists and a big thank you to everyone who entered and our 36 volunteer judges for running a fair and thorough process,” she says.
“Each year, the bar is raised in terms of entries and we continue to see businesses leverage their participation in the awards to promote and enhance their organisations, which is fantastic to see.”
The finalists announced will take part

in face-to-face interviews with judges, before winners will be announced at a gala event on Saturday, November 9.
Now in its 29th year, the awards celebrate large and small businesses across all industries.
“Small business is the backbone of Queensland and here on the Sunshine Coast, we are home to a thriving and entrepreneurial business community,” Ms Swaine says.
“The awards are about recognising the positive impact of small to medium businesses on the Coast and the role they play economically, socially and environmentally so we can create a better future for the kids who call the Sunshine Coast home.”
In addition to the 17 categories, the Export and Business of the Year winners will be drawn from the winners.
Hall of Fame Awards will also be awarded to businesses that have won their category three years in a row.
The annual event traditionally kicks off during Queensland Small Business Week in May, with an opportunity for businesses to attend information sessions, workshops and networking ahead of the Gala Dinner awards evening in November.
For the full list of this year’s finalists and to view past winners, visit sunshinecoastnews.com.au.
Local police are calling on Sunshine Coast residents to become part of a community safety initiative.
Homes and businesses fitted with security cameras are being invited to register their closed-circuit television (CCTV) cameras with the Queensland Police Service’s (QPS) Community Camera Alliance.
The community safety initiative launched in 2021 and is ongoing in a bid to crack down on crime.
“Officers will be able to access the details of your registration for the purpose of investigating crime,” according to a QPS statement.
“If police believe that your CCTV system can assist with an investigation, you will be contacted and asked to help.
“Residents and business owners who choose to be part of the Community Camera Alliance should be proud of their contribution to community safety.
“Sunshine Coast police sincerely appreciate your contribution to community safety by registering with this program.”
Registration details are securely stored on the police database and are only accessible by police on approved devices.
For more information about the program, visit police.qld.gov.au and search ‘Community Camera Alliance’.











Since last July we have helped ten local families achieve their well-deserved retirement. The team at Savvy Business are experts at matching buyers with quality businesses. Congrats to those families who are now loving life…are you ready to retire?



to explore, learn and connect with their peers and community.
“Each year, we have learnt from the year before and believe we now have the formula right,” Mr Forbes says.
“This year, we have over 30 community groups coming together to nurture and support parents, carers and our youth.
“Mental health is an extremely important topic and the knowledge and ability to assist our youth is needed now more than ever.
“This year also highlights new partnerships coming together as the community groundswell continues to flourish.”

The Nurture Festival returns for its third year, with First Nations artist Layla Havana joining the line-up. WORDS: Caitlin Zerafa.
Afestival that promotes creating a network of support for Sunshine Coast youth is building on its success as it heads into its third year.
Nurture Festival is a one-day free event dedicated to advocating for youth mental wellness through a variety of activities, workshops and talks. Since its beginning in 2022, festival co-founder Mark Forbes says the event continues to provide a safe space for teens




Mr Forbes says the festival is partnering with the Mooloolaba Rotary Club and the Eumundi School of Music, as well as continuing to work closely with local schools.
Festival highlights will include performances from local students, including from the Eumundi School of Music. There will also be drone racing, outrigger canoeing, panels and speakers.
First Nations singer/songwriter Layla Havana will be a part of this year’s line-up and says she is honoured to be involved with a festival that supports youth mental health.
“I think it is so great that there is more and more awareness being spread about
mental health as it is such an important topic,” she says.
“I have seen many kids my age struggle with their mental health and I’m sure lots of those kids would appreciate events just like this one.”
The 15-year-old Peregian Beach local recently toured alongside Katie Noonan, Melinda Schneider and Abby Dobson for the A Kind of Hush national tour. This follows the 2023 release of her debut EP, Beneath the Surface.
“My favourite song to perform is one of my originals called My Everything because it is about my mum,” Layla says.
“I love my mum more than anything. She means so much to me and that’s why I wrote her a song and love to play it.”
The Coast teen believes music is an important way for people to connect within communities.
“Songs can be written to express feelings and experiences by sharing those songs can lead to people relating to others and creating connections.
“I like writing music when I want to reflect on my experiences and express emotions, but I also enjoy coming together with the people that also love listening to music.”
Nurture Festival is happening on October 5. Visit nurturefestival.com.au to register for the free family-friendly event.













• Cash fl ow management




Punters Finance provides fast and fl exible funding solutions for small businesses, to help with:






• Paying overheads or unexpected expenses
• Investing in business growth





• Consolidating or repaying debt, including ATO debt













Cancer Council Queensland’s new wig and turban program is helping local people regain their confidence.
Every year more than 3000 Sunshine Coast residents are diagnosed with cancer.
To bolster support to patients, Cancer Council Queensland and Wishlist have teamed up to offer a service to address one of the major side effects of treatment.
Cancer Council Queensland’s wig and
turban service is now available at Wishlist Centre. It offers a personal fitting with a trained volunteer with a range of wigs and headwear to choose from, at no cost.
Local nurse and mother of two Kate McIllmurray had her life turned upside down when she received her breast cancer diagnosis in December 2023.
A month later she was booked in for a
double mastectomy, chemotherapy, radiation and began taking hormone blocking drugs that she will continue for the next 10 years.
The service has been a source of comfort for Ms McIllmurray, giving her some control over a situation where most cancer patients feel helpless.
“For most people who experience cancer, losing your hair is a big deal,” she says. “My husband and daughters had an afternoon cutting off my hair, because I didn’t want to lose it during chemo.
“I then went to Cancer Council Queensland for my wig and turban fitting and I got to try on some different turbans and get the different colours that would work with the clothes I wear most often. It was a really fun and helpful experience.”
Cancer Council Queensland’s Deanna Romain says as part of the service, its volunteers provide empathy, understanding, and validation to those undergoing cancer treatment.
“Cancer treatment is confronting enough as it is, but when people lose their hair, they often feel they’ve lost their individuality,” she says.
“It makes a huge difference in helping someone regain their confidence.”
Local patients can find out more by calling the Information and Support Line on 13 11 20.
A community garden has sprouted in one of the Sunshine Coast’s fastest-growing areas and scores of locals are ready to dig in and help it flourish.
The Harmony Palmview Community Garden will become a reality thanks to a grant awarded by the estate’s developer, AVID Property Group, and Sunshine Coast Council to create a biodiverse garden for residents to enjoy.
Harmony Palmview Community Garden Group’s Emma Miles says the initiative will foster a strong sense of community through shared activities and provide educational opportunities on gardening, sustainability and healthy living.
“The garden is all about creating connection amongst our members, as well as growing and having access to fresh produce to save a trip to the shops,” she says.
“The program has been a big work in progress, so it is fantastic to have assistance from community grants like this to support and kick start the program.
“We have already had more than 260 community members express interest in joining the garden group and we can’t wait to see the garden and the community we create flourish.”









Join the Walk in Wings event to support people living with a disability.
ASunshine Coast disability organisation is calling on the community to lace up their shoes and spread their wings for the fourth annual Walk in Wings event.
Sunshine Butterflies is hoping to raise $20,000 at the event to help with the running of its six-hectare property.
Founder and CEO Leanne Walsh says the organisation’s Farmability program and farm animal therapy sessions provide members with a safe and supportive space to care for and interact with farm animals.
“Connecting with animals through body language, caring for them and helping maintain their living environments really has a special way of boosting social connections, self-confidence and a sense of accomplishment.”
Ms Walsh says the money will go toward purchasing machinery, which will make a difference in reducing physical strain and helping members, staff and volunteers work more efficiently.
“Currently our main responsibilities like feeding, waste disposal and manure spreading are done manually using wheelbarrows. [The machinery] will improve the wellbeing of our cherished farm animals and the safety of our members, staff and volunteers.”
The three-kilometre walk will take place on October 11 from 6am along the Noosa River, starting and finishing near the pirate playground.
Register via walkinwings.com.au.

If you are between 18 and 50 years of age and in good general health, you may be eligible to participate in the trial of vaccine.
Join our trials, contribute to medical research.


Australian entrepreneur Mark Bouris will headline a breakfast event to challenge Sunshine Coast business leaders to play a bigger game.
Mr Bouris is an author, podcast host, television personality and famously known as the founder of Wizard Home Loans, which disrupted the finance industry and took on the Australia’s big four banks.
He is known as a formidable leader who uses his knowledge and experience to grow and nurture the next generation of Australian success stories.
The Maroochydore Chamber of Commerce has secured Mr Bouris for its breakfast event at Maroochy RSL on February 20, 2025.
Chamber president Brendan Bathersby says it will be an extraordinary event not to be missed.
“Mr Bouris has a reputation for ‘telling it straight’, and right now, that is the energy we need in a growing and evolving region that is being continually disrupted.
“As a chamber, we see a very bright future, where having leaders prepared to question the status quo will be critical.
“This breakfast will highlight the opportunity available in any challenge, indicative of a growing region.

We are seeking individuals over the age dementia to participate in the trial of a potential treatment for early stages of

“In periods of uncertainty, where our region and business landscape is changing so dramatically, insolvencies are being reported regularly and new economies are emerging, we feel a deep responsibility to provide our members and the business community with every opportunity to strengthen their mindset and face challenges head on.”
The event is open to the general public. Early bird tickets are now available via maroochy.org.
Contribute to bringing advanced treatments and breakthrough therapies to our regions.


If you, or someone you care for is associated with dementia, there may be an opportunity to participate in the trial of a potential treatment reducing dementiarelated agitation.
Understand your own health to help others.

assorted model boats ranging from speed boats to sailing craft. Then on September 29 the club will hold its Vintage Sailing Craft Regatta. Find the club at The University of the Sunshine Coast Lake. Enter the university via the main entrance and follow the ring road to the left, following the signs to the lake. Visit scmbc.org.au.

Community projects including emergency response, disability surfing, youth development and theatre are to share in more than $110,000 from the Buderim Foundation’s 2024 Community Grants Program. Buderim Foundation chair Rod McKinnon says the foundation is pleased to be assisting 22 different community organisations supporting the people in the wider Buderim area in this year’s program. “Since the first grants were provided in 2008, a total of $940,031 has been distributed to 105 community organisations.”
Visit buderimfoundation.org.au for more information on the foundation.
The Guilded Lilies Sewing Group meet on the last Saturday of every month. The next meeting is happening on September 28 at the Masonic Hall on Moorindal Street, Tewantin from 9am to 3pm. Everyone is welcome to come along, meet new friends and learn new skills, with all handcrafts welcome. For more details phone Angela on 0408 068 148.
The Sunshine Coast Model Boat Club will hold a come and try day on September 28 from 10am-1pm. Families can try driving


As part of the Sunshine Coast Seniors Festival, which coincides with Senior’s Month, a Senior’s Expo is at Maroochy RSL on October 1. From 9am to 2pm the expo will showcase the best the Sunshine Coast has to offer, with a wide range of seminars and exhibits. Visitors can explore topics ranging from health and wellness to technology and hobbies. The expo aims to create a community where people not only age well, but thrive. Visit scseniorsfestival. com.au for more information.
Coolum Art Collective is presenting its spring exhibition across four days in October. More than 200 original artworks by 20 local artists using a variety of mediums will be on sale. This includes watercolour, pastel and oil works depicting local coastal and hinterland scenes. Entry is free and visitors will have the chance to vote for people’s choice. The event is on October 4 to 7 at the Coolum Civic Centre. Doors open at 9am-5pm, Friday to Sunday
and 9am-3pm, Monday. Visit coolumartgroupinc.com.au.
Blackall Range Woodies open day
The Blackall Range Woodies is holding an open day on October 5 and 6 from 9am-3pm. ‘Woodies’ members have been very busy making wooden bowls, boxes, carvings, coffee tables, stools, toys and an array of interesting and useful articles, which are ideal for Christmas presents. Head along to the club’s shed at Montville Sportsground, 230 – 238 Balmoral Road, Montville. Members also annually donate wooden toys to the Salvation Army Christmas Toy Appeal.
Probus Club of Currimundi
Combined
The Probus Club of Currimundi Combined meets on the second Wednesday of the month at the Caloundra Indoor Bowls Club, 55 Burke Street, Golden Beach. The next meeting is on October 9 at 9am. The group also holds regular social activities and outings, plus a monthly barbecue breakfast. Visit probuscurrimundi.org or contact Glen on 0417 431 440 for more information.
Do you have a community notice? Email it to localnews@ myweeklypreview.com.au.
























































































































Cr Ted Hungerford Division Seven
Budget highlights
It is fantastic to see the new car park on Main Street, opposite Buderim Mountain State School, already being well used by our community. It provides 40 parking spaces, including one disability space. The design and landscaping have certainly made it much more in keeping with the rest of Buderim village. More funds to support our community groups
I’m pleased to report council has approved almost $1.2 million in Community Partnership Funding to help 144 not-for-profit groups across our region continue to thrive. We have several local organisations in my division that will benefit, allowing them to continue helping our community, including the Buderim Historical Society and the Buderim Library Association, among others.





Power Road and Dixon Road upgrade continues
This crucial intersection in Buderim is on track to be completed in the coming months. The $5.8-million upgrade will significantly improve safety for pedestrians, cyclists and drivers. It won’t be long until we can all enjoy new traffic signals with dedicated walking and riding crossings, a separated two-way cycle track, pedestrian pathway and additional traffic lanes.
It’s playtime at Deloraine Drive Park
We’ve installed fabulous new play equipment, a new playground fence, new footpath and seating, completed in time to enjoy as the weather warms up. With a new shade sail protecting the playground and new shade trees and landscaping, it’s time to have some fun!
Staying in touch
If you have any suggestions or feedback, you can contact me at ted.hungerford@ sunshinecoast.qld.gov.au. To keep on top of what is happening in Division 7 please keep an eye out for my regular newsletter. If you’d like to report any concerns such as road hazards, graffiti or dumped rubbish, you can contact council direct, either by the service request form available at sunshinecoast. qld.gov.au or call 5475 7272.











































The festival is a cornerstone of Seniors Month on the Sunshine Coast, highlighting the incredible contributions, talents, and experiences of our senior community. Whether you’re looking to engage with local organizations, learn something new, or simply enjoy a day out, the festival promises a vibrant lineup of exhibits, seminars and entertainment.
SEMINARS TO ATTEND
Rooms 1-3: 12pm-2pm
Book your seat online or on the day. Visit www.scseniorsfestival.com.au
ROOM 1: 12-1PM
Understanding the Dementia Journey: From Symptoms to Management with Dr. Sam Hutson
ROOM 1: 1-2PM
Demystifying Wills and Estates: Essential Knowledge for Planning Your Future with esteemed Lawyer Trent Wakerley
ROOM 2: 1-2PM
Connecting Community – Celebrating Life THANK



SENIORS EXPO TUESDAY, octOBER 1 9:00AM - 2:00PM
Planning for Peace of Mind: A Guide to Advance Care Planning with Dr. Wendy Kinton
ROOM 3: 1-2PM
Walking the Alzheimer’s Journey: A Story of Love, Care, and Resilience with Vincent O’Rourke

...






Maroochy RSL 105 Memorial Avenue, maroochydore exhibits // workshops live entertainment




RISE2 FOUNDATION MELBOURNE CUP DAY LUNCHEON
The RISE2 Foundation is gearing up for its second Melbourne Cup Day event. Tickets include a welcome drink on arrival, two-course lunch with proceeds to support the foundation, which provides safe housing for local women and child survivors of domestic violence. There will be sweeps tickets, raffles, a silent auction and jewellery parade by designer and sponsor Jo Saxelby of To Hold & To Have, Buderim. MC Kristy Munroe AM will host the event. By attending you can help make a difference.
When: Tuesday, November 5, 11.30am-3pm.
Where: The Lakehouse, 15 Freshwater Street, Mountain Creek.
Tickets: $125 via trybooking.com/ events/landing/1284880.
There’s loads to explore and plenty to do on the Coast. Pop these fun events into your diary so you don’t miss out.
SEPTEMBER A HOME AMONG THE GUM TREES GUIDED WALK

It’s koala season at the Maroochy Bushland Botanic Gardens. Join a guided walk along the Lagoon Walk to learn about the eucalypt species that koalas love to eat and uncover fascinating koala trivia. Suitable for families, this walk covers paved and gravel surfaces in a natural bush setting. Meet at the Arts & Ecology Centre entrance.
When: Saturday, September 28, 10-11.30am. Where: Maroochy Bushland Botanical Gardens, Tanawha. Tickets: $5 via eventbrite.com.au. Search ‘A Home Among the Gum Trees Guided Walk’.





Relive






FEAST
The Feast Fest: World Food Fair promises an explosion of global flavours with more than 30 food vendors offering an array of cuisines. From Greek souvlaki to Mexican tacos, Italian pasta to German bratwurst, every craving is covered. Enjoy live entertainment that captures diverse cultures, from Japanese Taiko to Samba. The event, held at Brouhaha, also features the Sunny Coast Street Food Cook-Off, a thrilling showdown of culinary talent. Mark your calendars and join this vibrant celebration of food, culture and community.
When: Saturday, September 28, midday to 8pm.
Where: 1 Edison Crescent, Baringa.
Tickets: Free entry. Register via events. humanitix.com/feast-fest-world-foodfair?hxchl=hex-pfl/tickets.

FRIDAY, SEPTEMBER 27
Craig Atkins, Sol Bar, 5pm
Pasiflorez, Sol Bar, 8pm
Simon Meola, Maroochy RSL, 5.30pm
Chris Ramsay, Coolum Surf Club, 8.30pm
Raw Ordio, Alex Surf Club, 4pm
Ollie Murk, Maroochy Surf Club, 7.30pm
DJ Moto sas, Palmwoods Hotel, 8.30pm
DJ La Boum, Beerwah Hotel, 8.30pm
SATURDAY, SEPTEMBER 28
Latin Dance Festival, Banana Bender Pub, 7.30pm
Matty Rogers Band, Norton Music Factory, 6pm
A Musical Affair, Eumundi School of Arts, 6pm
Balin Forever Festival, The Station, 5pm
Cosmic Vice, Sol Bar, 7pm
The Shrubs, Maroochy RSL, 5.30pm
Alexis, Coolum Surf Club, 8.30pm
Chris Ah Gee, Maroochy Surf Club, 7.30pm
Bad Habits, Palmwoods Hotel, 8.30pm
The Fortunate Sons, Beerwah Hotel, 8.30pm
SUNDAY, SEPTEMBER 29
Goaled, Black Box Theatre, 2pm
Creedence – John Fogarty Show, Kings Beach Tavern, 3pm.
* All events were correct at time of printing.




Onyx Poppy Boutique
New season event wear is in store featuring the Cardelina dress by Sacha Drake. Onyx Poppy Boutique Shop 5/47 Burnett Street, Buderim, 5477 0902. onyxpoppyonline.com.au



Lordes kaftan dress, Meraki Thread Co, Shop 28, The Wharf, 123 Parkyn Parade, Mooloolaba. merakithreadco.com.au





Avenue J Jewellery, Mooloolaba, 5444 4422. avenuejjewellery.com.au


Elevate your wardrobe with the Minali Silk dress in Sunset Orange, the ultimate choice for special occasions.
Lara J Mooloolaba, Shop 113/101-105 Mooloolaba Esplanade, Oceans Resort Mooloolaba, 5478 4003.



Treasure Store
This tailored dress is flattering to wear with the draped waist, centre back zip and darts. Blue/grey and champagne, sizes 6-14, $99. Available at both our Treasure Stores. The Wharf Mooloolaba, 0488 288 250 Hastings Street Noosa, 0434 320 130

Step into Spring with our beautiful range of cotton and linen essentials. Featuring the Isabella Maxi Dress from our new label Ivy & Jack. rayanna.com.au @rayannacaloundra

platinum and 18ct
and


Celebrating 20 years!

Custom, handmade jewellery tailored to your style and budget, using the finest gemstones. NY2K Jewellers, Shop 5, Rovera Plaza, 23 Cotton Tree Parade, Cotton Tree, 5443 1955. ny2k.com.au NY2K Jewellers
Contact Patricia to arrange a booking to find your dream dress, whether it is for your formal, an evening out, mother of the bride/groom, bridesmaid or the bride, we have a huge selection of gorgeous gowns. 2/137 Brisbane Road, Mooloolaba 0417 777 059. angelsformalwear.com.au















Are you tired of trying products that don't deliver results? Rest assured, the team at Australia Cosmeceuticals understand your frustration. That's why they’ve created the Miracle 11 Complete Skincare Kit, guaranteed to deliver noticeable results in just five days –or your money back. Indulge in the affordable luxury of our organic-certified, Australian-made cosmeceuticals. Begin your journey to a younger, more radiant you today.
Call Cher on 0408 200 059 or visit australiahifu.com.au.







Do you need help with your style or struggle deciding what styles suit you? Would you like a wardrobe makeover that matches your budget?
Sunshine Plaza personal stylist Sheree Johnstone can help. Sheree has empowered thousands of men and women to gain confidence with their style every day. Find out more at unseenstyling.com.au or visit The Style Hub at sunshineplaza.com.






Ashley Robinson’s recent trip home from the big smoke challenged his patience and his relationship with technology.
wrote a column the other week about AI and how we are reliant on it. Last weekend, I lived that dream.
I had my Thunder netball hat on and I had to go to Nissan Arena at Mt Gravatt for the state titles.
On the way, I had to make a quick detour to Manly to drop something off to one of Old Mate’s friends. I have never been to Manly, so GPS was in play.
I must say, Manly is an awesome spot. If I had to live in the big smoke, that would be where I would live.
Anyhow, the GPS worked great. I got to both destinations intact and on time. Unfortunately, getting home was different – a great example of my stupidity.
When I left, I decided I didn’t need the GPS as it was memory-based travel from way back when the Broncos used to play at the arena. I knew where I was going.
After a few kilometres and a few sets of lights, though, I started to have doubts.
I pulled up within view of what I thought was the motorway and the road home.
Just to be sure, I whacked in my address, and it told me to do a U-turn.
Thirty minutes later, I found myself on the Pacific Highway heading south. Bizarre.

The first chance I got, I pulled up and checked my destination.
Street name – tick. House number –tick. Suburb – Currumbin. Massive fail, and another reason I need to keep a set of glasses in the car.
So, I put the right address in, and you guessed it, the GPS took me back past the exact spot I had sat 30 minutes earlier.
This is what I learnt last weekend: never eat the karaage chicken at Nissan Arena unless you want indigestion for 24 hours.
When stressed, never pull up at a service station and buy two bags of snakes because it is cheaper than one. You’ll end up eating the whole lot and add a sore jaw to the indigestion.
And thirdly – and most importantly – never let IT override common sense to the point of knowingly being led south when your tiny brain is telling you that something is astray.
I wonder if GPS has a common sense app? It seems it is certainly not common in my world.
data revealing Australians spent $32 billion on in 2022/23, Jane Stephens is calling on the community to take a break.
et’s bench the bet, just for a month: pokies, horses, footy, the Lott. As a trial, let’s file what we fritter away and see how much money is saved. It will be tough, with footy finals and broadcast ads shouting at us in every ad break to punt and play. Because boy, do we like to do both.
We Aussies laugh off criticism of gambling. We say it is cultural, that Australians have always had a predilection for a bet. But frocking up and throwing money on a horse that you know nothing about, or going to dinner at a club and finding yourself throwing money down the throat of a machine that flashes and beeps is money for nothing – akin to throwing it in the bin.
A little zing of dopamine is delivered perhaps, but that is one costly little buzz.
The house always wins and we are world-class losers – losing more than any other nation, with critics blaming the lack of regulation. The losses are growing year on year. The Queensland Government Statistician’s Office data revealed this month Australians lost $32 billion in 2022/23: $23 billion from gaming (mostly
poker machines, but casinos and lotteries too) and a further $9 billion from wagering – betting on sport and racing.
The problem is, so much depends on parting people from their pennies.
Community groups receive donations raised by people’s losses through club funds. There are the pretty maidens all in a row at the races that fund a whole industry. TV stations and sporting codes currently depend on gambling ads to survive.
The latest numbers show Australians are now throwing more than $1500 per capita away on gambling. Half a million Australians have asked their banks to temporarily ban them from having a punt. It is no longer a naughty guilty pleasure: our gambling losses are causing social harm, but to turn the tide is something we are going to have to do ourselves.
Our economy is so dependent on it that the Federal Government has warned against a total ban because such a thing would cause media companies and community groups to fold. While it takes baby steps, let’s sample walking away and keeping more dollars in our pockets. Let’s decide not to be losers anymore.

Troy Davey , Ord Minnett Buderim
Earlier this month the Australian Prudential Regulation Authority (APRA) proposed changes to the capital framework for banks which would result in the phasing out of Additional Tier 1 (AT1) capital, or hybrids as they are commonly known.
Since the failure of Credit Suisse last year, which saw US$17 billion in AT1 notes wiped out, the regulator has been concerned that AT1 securities do not absorb losses until the very late stage of a bank failure due to “the complexity of using it, the potential for legal challenges and the risk of causing contagion”.
However, Credit Suisse hybrids were structured differently to Australian hybrids which is an important distinction.
AT1 capital has never been tested domestically reflecting the strength of the domestic banking system, but APRA suggested that the international experience (i.e. Credit Suisse in 2023) has shown that AT1 capital had not been effective and complicated resolution.
The key concern is that AT1 absorbs losses only at a very late stage of a bank failure. According to APRA, the Credit Suisse case in 2023 highlighted that AT1 features for early loss absorption in a going concern were not effective. It’s suggested that AT1 only absorbed losses when the point of non-viability was imminent and failed to stabilise the entity at an earlier
stage of stress. If AT1 was used in Australia, APRA considers it would not fulfil its role in stabilising the bank before non-viability was reached. There is a lack of evidence to support this suggestion.
APRA had three policy options to explore – 1. Maintain the status quo, 2. Redesign AT1 notes to improve their loss absorption ability, or 3. Replace AT1 notes with other forms of capital.
The policy route chosen by the regulator is to gradually replace AT1 notes with Tier 2 capital or Common Equity Tier 1 (CET1) capital. The changes would only affect banks and would not impact insurers given banks present more of a systemic risk than insurers do.
Under the proposed approach, large banks (i.e the majors, Macquarie and ING Bank) would replace their 1.5 per cent of AT1 hybrids with 1.25 per cent of Tier 2 debt and 0.25 per cent of CET1, while smaller banks will be able to fully replace their AT1 with Tier 2 capital.
The proposed changes are not final and APRA is seeking feedback as part of the consultation process with a range of industry bodies over the coming months.
The announcement is positive for existing holders of hybrid securities given the supply will be in run-off while demand for regular franked income persists. We will be disappointed if the decision to phase out hybrids is final given they offer a lower risk profile than comparable assets, but offer generous returns.
GATES









Lauren is here to help!
We understand that figuring out Aged Care can be daunting. So at Immanuel Gardens, we go above and beyond to make things easier. We offer a dedicated Client & Community Advisor, Lauren Foster, who will happily answer all your questions. So don’t try to work it all out on your own—call Lauren at Immanuel Gardens today.
Troy Davey is an Authorised Representative (no 473122) of Ord Minnett Ltd, AFS licence 237121. He can be contacted on 07 5430 4444. This article contains general financial advice only and does not consider your personal circumstances; you should determine its suitability to you and consult a financial adviser and consider the relevant product disclosure statement before purchasing a financial product. Past performance is not a reliable indicator of future performance. To find out more, call or email Lauren today. p. 1800 960 433 | e. lauren.foster@lutheranservices.org.au



Lauren can help you with:





































Whether you’re planning for a baby or already on this incredible journey, our naturopaths are here to offer support and guidance.
Improving gut health, supporting your immune system and taking a personalised approach to enhance your overall fertility can support pre- and post-natal care.
Preconception is an important time to implement any dietary and lifestyle changes needed. Reducing inflammation is a great place to start, alongside limiting or removing any food choices and alcohol that contribute to inflammation.
Folate is an essential B vitamin during pregnancy as it helps with red blood cell formation for healthy growth and function. This nutrient supports health development of baby’s brain and spine –so load up on dark leafy greens, asparagus, citrus fruits, broccoli – and look for a good quality supplement during pregnancy to ensure adequate supply.
Omega 3’s are an essential nutrient group to boost, to help baby’s brain and retina development. Our body needs this from food and supplement sources such as oily fish, flax seeds or a quality omega supplement. While it’s important to eat a
rainbow of organic, health foods during your life, if considering pregnancy, trying for a baby, during and after pregnancy, it’s even more important to watch your food choices. Iodine, vitamin D, zinc, selenium, B vitamins, calcium and vitamin C are important to prepare and fuel both mum and bub.
Organic wholefood sources are the best place to start (ask our team in store to help guide you) and good quality supplements can help take the pressure off. Remember to prioritise rest, self-care and surround yourself with supportive energy.
Food is full of vitamins
Oranges and broccoli are packed with folate, which is important for baby’s neural formation and spinal health. Folate also helps form red blood cells – be sure to choose organic where possible to ensure maximum vitamin quality, eliminating any inflammatory-causing pesticides from conventionally grown produce.
Dulse and Nori are great daily additions to your diet to maximise iodine levels for thyroid hormones. Adding beef liver to your diet is a natural wholefood source of vitamin A, B12 and folate as well as heme iron to support both mum and baby.
WORDS: Assunta Hamilton, Kunara Organic Marketplace naturopath.
Visit Kunara, 330 Mons Road, Forest Glen or kunara.com.au.
Products we love
1. Naturobest Preconception: Naturopath designed and formulated multi vitamin to boost essential vitamins and minerals needed during preconception phase
2. Herbs of Gold Activated Folate 500: A great supplement for healthy foetal development when baby is in the womb, especially with regards to neutral and brain development.
3. Ancestral Nutrition beef liver: High in iron, B vitamins and folate.
4. Phytality Clean Omega & Nordic Naturals Cod Liver Oil: Omega 3 is important for brain, heart and muscular skeletal function. Supportive for your entire pregnancy journey. High in DHA which is a much-needed nutrient when you are pregnant.
5. Nature’s Sunshine Fenugreek: Can help to stimulate milk production. For prenatal and pregnancy support, pop in store at Kunara Organic Marketplace and speak to one of our friendly naturopaths. We’re here to help you through this journey – whether it be with herbal supplements, dietary advice, or general support.
























In today’s health-conscious world, people are increasingly aware of the need for regular detoxification. One of the most overlooked but crucial forms of detox is a parasite cleanse. Parasites – microscopic organisms that can live in our bodies undetected – may contribute to a variety of health issues, including digestive disturbances, fatigue, skin conditions and a weakened immune system.
A parasite cleanse focuses on ridding the body of these organisms by using natural herbs and dietary adjustments. It’s an essential step toward restoring balance in the gut and overall wellbeing.
Cleansing alone is often not enough to fully eliminate the toxins and waste left behind as parasites die off. This is where colon hydrotherapy, or colonics, comes in as a powerful complementary therapy.
Colonics provide a gentle, effective way
People with missing, broken-down teeth, often put off treatment due to dental anxiety, fear of dental impressions, a strong gag reflex, claustrophobia or due to time constraints. They may now have a solution.
Mrs L, a 60-year-old female patient, was treated by a team of Sunshine Coast specialists – Dr Ramman Oberoi and Dr Ian Wilson – using a digitised guided surgical approach, AuDentes®, developed by a Melbourne prosthodontist, Dr Philip Tan.
Her existing compromised teeth were replaced by new implant-supported fixed bridges in a single surgical procedure in a day surgery setting in a hospital.

to flush out the colon, removing built-up waste and debris that can harbour parasites.
As the colon is cleansed, it creates an environment that is less hospitable to parasites. Additionally, colonics help reduce common symptoms associated with cleansing, such as bloating, gas and headaches.
By incorporating colonics into a parasite cleanse regimen, individuals can enhance the overall effectiveness of the process, ensuring that the digestive system is not only parasite-free but also healthier. A clean colon is vital for proper nutrient absorption, immune function and overall energy levels.
Visit sunshinecolonics.com.au or phone 5326 3537.


AuDentes® offer instant teeth with removal of existing teeth, implants placements and final fixed bridges, all done in one day under one procedure, with comparable costs and minimal time. Some costs may be covered by your Medicare and private health cover, too.
If you are unhappy with your teeth or dentures and are considering options to replace them, contact us for a consultation.
Ramman Oberoi Prosthodontics, 5444 5679 or email: bookings@ rammanoberoi.com.au.






begins with a healthy gut.


















Discover the key to optimal health and well-being. At Sunshine Colonics, I specialise in Colon Hydrotherapy, helping you cleanse, rejuvenate, and fortify your gut for a healthier, happier you.
•Revitalise Your Gut:
Experience the benefits of a healthy colon with our expert colonic hydrotherapy sessions.
•Boost Immunity:
Strengthen your body’s defenses by maintaining a balanced microbiome.
•Detox & Renew:
Gentle, effective cleansing to help you feel lighter and more energised.
•Personalized Care:
Tailored treatments to suit your unique health needs.
•Book Today:
Invest in your wellness and discover the transformative power of a clean, healthy gut!
SUNSHINE COLONICS HEALTH & WELLNESS CENTRE
A U3 82 Parker St, Maroochydore QLD 4558
T 07 5326 3537
E info@sunshinecolonics.com.au
Wsunshinecolonics.com.au

The first Wednesday of every month SAVE 20% off all vitamins & supplements +





From AI advice to leadership tips, there will be something for everyone at the upcoming Thriving Through Change Business Expo.
The highly anticipated Thriving Through Change Business Expo is back on October 29 from 2-8pm at the Maroochy RSL.
Now in its fourth year, Sunshine Coast Council’s signature business expo is open to all businesses across the region to attend for free.
Attendees can learn and benefit from
two masterclasses, a motivational keynote address and an evening of networking.
You’ll find a wealth of support and resources at your fingertips with an exhibition offering direct access to more than 35 local, state and federal government support agencies, plus the region’s chambers of commerce and

industry groups.
Whether you are a sole trader, a small business with a few staff or a company on a growth trajectory, there will be something for you at Thriving Through Change.
It’s also a chance to build connections, learn new skills and prepare for the future in a supportive environment.
PURPOSE-DRIVEN LEADERSHIP – Don’t miss the keynote from Dave Clare, a nationally recognised advocate for leadership and workforce-driven success.
As the CEO and founder of Circle Leadership Global, Mr Clare has dedicated his career to empowering leaders to foster environments where every voice matters, decisions are shared and leadership is about purpose and outcomes, not hierarchy and tasks.
His insights into building strong, purpose-driven businesses that can adapt and evolve through change are valuable.
You’ll also have the chance to attend two practical masterclasses designed to build your business capability.
MASTERCLASS – MAKE AI YOUR ADVANTAGE: REAL SOLUTIONS FOR REAL BUSINESS CHALLENGES – This masterclass will give you the confidence to use AI to your advantage rather than be overwhelmed by it. You’ll learn of real AI tools and strategies that are simple to


implement into your business with the purpose of making you and your team more effective in your operation to free up time and save costs.
MASTERCLASS – STRENGTHEN CYBER
SECURITY IN YOUR BUSINESS – This cyber security masterclass will take you through what you need to know about the threats, vulnerabilities and risks you may face. Learn practical steps to manage cyber risks and set your business up to become resilient to attacks in the future.
NETWORKING – Finally, the expo wraps up with a social networking session – a great chance to relax, catch up with familiar faces or make new connections. Join us for a day of learning, connecting and growing together.
EVENT PROGRAM
• 2pm – Event opens
• 3.15-4pm – Make AI your advantage: Real solutions for real business challenges
• 4.15-5pm – Strengthen cyber security in your business
• 5.30-6.30pm – Keynote, Dave Clare
• 6.30pm – Networking
• 8pm – Event close
WORDS: Cr Terry Landsberg, Economic Development Portfolio Councillor






















































New Right to Disconnect laws came into effect last month and recent polls conducted by people2people recruitment reveal 78 per cent of employees are more likely to work for a company with a clear Right to Disconnect policy.
However, Australian employees and businesses have expressed concerns when it comes to its implementation and management.
Suhini Wijayasinghe, head of HR Solutions at people2people Recruitment, says, “From an employee perspective, I know firsthand how difficult it can be to set clear boundaries, especially when you work from home.
“This isn’t always possible and becomes even more challenging to apply when working with overseas teams as the time difference gets in the way, but also with teams that benefit from flexible work hours.”
The survey also revealed Australians’ main concern as employers will most likely be the difficulty to enforce such rules, followed by the impact on work culture, on productivity and collaboration.
Ms Wijayasinghe adds, “While enforcing the Right to Disconnect might be challenging both for employers and employees at the start, it is positive news and will benefit employees’ work-life balance and mental health”.
Tips for employers to implement the Right to Disconnect:
Communicate – Ensure that your right to disconnect policy is clear and easily accessible to all employees and ensure management communicates it on a regular basis.
Provide training sessions – Provide training sessions for management and staff on the new laws, emphasising the importance of respecting personal time and the benefits of a healthy work-life balance.
Lead by example, always – Promoting a culture that values work-life balance can’t happen if management doesn’t follow it in the first place. Encourage all employees to fully disconnect after working hours.
Monitor and adapt – Your first policies will most likely need a review as your company learns better ways
Right to Disconnect. Gather feedback from employees and be open to adjustments that better serve the team.
Use technology wisely tools that support the right such as email or messaging systems that can schedule communications during work hours or automatically notify senders that recipients are unavailable outside of these hours.

If you have been asked to be an Attorney for someone under an Enduring Power of Attorney (EPOA), you might consider it quite an honour.
An EPOA is a very powerful document and the person appointing you typically trusts you implicitly.
You can’t, however, be forced into the role and you should consider it carefully before signing the EPOA to accept your appointment.
What if, after accepting your appointment, you decide that you can no longer fulfil the role?
I recently had a client who had taken on the role with the best of intentions, but his circumstances changed significantly and he asked me how he could “get out”.
The answer depends on whether the person who made the EPOA still has capacity.
If the answer is ‘yes’, it’s as simple as the Attorney providing them with written notice (i.e. a letter or email of resignation).
If the answer is ‘no’, it’s not so simple.
In that scenario, the Attorney needs to apply to QCAT for leave to resign.
QCAT can then ensure a person who has lost capacity isn’t left without someone to help them and, if required, QCAT can appoint an appropriate replacement.


Some questions you may ask yourself?
If the answer to any of these questions is no, you will need to consider some of the following tactics:
Are you on target to meet your budgeted sales level? Review your marketing strategies.
Are all your products making a positive contribution? Consider doing a product profitability analysis which will analyse the relationship between selling price and total unit cost, demand for a product and break-even analysis.
Is your level of gross profit high enough? Review your pricing strategies or reduce your cost of sales.
Aged debtors too large? If the level of debtors rises, this could be because your sales are increasing or because your debtors are taking longer to pay.
Are you still profitable? Review your budget to note what is the underlying cause of your profitability issues.
Do I have enough working capital? If you do not have enough working capital you will not be able to meet your financial commitments. Customers need to pay faster, review stock on hand, as well as overheads.


KATRINA BRENNAN DIRECTOR,

When couples separate, deciding who retains the family pet can become a contentious matter. Pets are often considered cherished members of the family and both parties may have formed deep emotional bonds with the pet over the course of their relationship.
There are no specific provisions for pets in the Family Law Act 1975 (Cth). The Court does not have jurisdiction to make time arrangements in relation to a pet, as it does in parenting matters. Instead, pets are considered assets similar to a house or car.
While pets are legally considered assets, their emotional value often far exceeds their monetary value. In most cases, pets are of low-financial value unless they possess significant monetary value, such as racehorses or pedigree dogs used for breeding.
Some of the factors the court may consider when determining pet ownership include who the registered owner of the pet is, who the pet resided with prior to the relationship, who is responsible for payment of costs, including pet insurance, veterinary bills and food costs, who can provide suitable accommodation and care for the pet ongoing.
The best approach to resolving pet ownership disputes is negotiation. If parties cannot reach an agreement, seeking legal advice from an experienced family lawyer can help navigate this process.



Idyllically situated in the UNESCOdesignated Sunshine Coast Biosphere, Sunshine Coast Grammar School is creating generations of well-rounded and forwardthinking Australians.
The school takes advantage of its special location to develop students who are not only strong advocates for the environment but also accepting of all.
The key elements of the overarching, whole-school framework – people, planet and progress – have been driven by the visionary leadership of principal Anna Owen. “My role is to provide pathways for a diverse community of students and help
them find their interests and passions during their time at school,” she says.
“The students often raise the issue of the extent of any moral duty owed to their generation and future generations.
“Our program helps the school plan and educate our current group of students while concurrently being mindful of our future students, our community and the natural environment they will inherit.”
Adding to the challenge of these ambitious goals is the reality that it is not an easy time to be an education leader, as communities now seek schools to provide meaning and purpose within the context of the classroom. Schools are
part of the public debate and are expected to contribute.
“There is a managerial or leadership revolution in education that has been emerging for a number of years,” Mrs Owen says.
According to United Nations data, the global population will increase by two billion by 2050, which gives the concept of intergenerational justice particular weight. In creating the school’s framework, Mrs Owen researched the United Nations’ 17 Sustainable Development Goals, and realised they dovetailed with her own vision.
Describing the impact of introducing the UN goals, Mrs Owen explains, “They have given our school a sense of purpose and the knowledge that we are contributing to the greater good.
“We teach that everyone should be treated with respect and dignity no matter when or where they are born and that we should not make decisions that will cause harm to future persons.”
“As a non-selective, co-educational school, we have struck a balance between economic considerations and the sometimes-competing aim of not inflicting harm on future individuals.
“The goals incorporate growth in industry, infrastructure and innovation and encourage decent work and
economic growth, and of course, education,” Mrs Owen says. All of these efforts under Mrs Owen’s leadership have resulted in a series of schoolwide accolades:
• A seven per cent rise in enrolment since 2022.
• Eighty-six per cent of staff recommended working at the school, and 76 per cent were highly engaged.
• Named one of The Educator’s Most Sustainable Schools in 2023 and 2024.
• Finalist in The Educator’s Education Awards for Regional School of the Year 2023 and 2024.
• Finalist for The Educator’s Education Awards for Best Cocurricular Program in 2024
• Included in the Top 10 Queensland schools according to ATAR results, with two students receiving a perfect score of 99.95 in 2023.
Mrs Owen has also been honoured as one of the Most Influential Educators of 2024 by The Educator, selected to attend the UNESCO Inclusive Schools Forum in 2024 and invited to become a member of the UNESCO Global Schools Principal’s Forum. She is the Sunshine Coast Council Biosphere Community Advisory Group chair and a director of the Independent Schools QLD Board. Visit scgs.qld.edu.au.

1 Unfortunately (5)
4 Caustic (9)
9 Inconsistent (7)
10 Flees (7)
11 Introduction (5)
13 Become liable to (5)
15 Frozen water (3)
16 Generation (3)
17 Acquiesce (5)
19 Guiding maxim (5)
21 Crypts (5)
23 Transparent (5)
24 Bowler (3)
25 Title (3)
26 Holding (5)
28 Sharp ringing sound (5)
29 A breakfast food (7)
31 Sparkle (7)
33 Personal driver (9)
34 Nose-related (5)
DOWN
1 Unwavering (9)
2 Hardy (7)
3 At present (3)
4 Desert plants (5)
5 Regret (3)
6 Transpire (5)
7 Stamp (7)
8 Result from (5)
12 Defrosts (5)
14 Pancake (5)
18 Sways to and fro (5)
19 Deserve (5)
20 Having eight straight sides (9)



ARIES (MAR 21 - APR 19)
The solar eclipse revs up your relationship zone, so you’ll experience the greatest satisfaction if you share your goals and dreams with like-minded people. Collective collaboration is the key. But you need to think long-term and be patient.
LEO (JULY 23 - AUG 22)
You’re in the mood to talk as the solar eclipse activates your communication zone. New connections within your local community are also likely. But there’s a Mercury/Mars square, so make sure you convey your message clearly and concisely.
SAGITTARIUS (NOV 22 - DEC 21)
The mid-week solar eclipse is the perfect time to revise, reassess and reboot your hopes, goals and dreams for the future. Think of creative ways you can navigate the unpredictable economic landscape, adapt professionally and pivot personally.
TAURUS (APR 20 - MAY 20)
The mid-week solar eclipse stimulates your daily routine/work/ wellbeing zone (and taskmaster Saturn trines your ruler Venus). So it’s time to be disciplined as you draw up a to-do list, apply for a new job, or reboot your diet and exercise routine.
VIRGO (AUG 23 - SEP 22)
The mid-week solar eclipse signals a fresh financial chapter, so start planning now. Long term partnerships (of the romantic, platonic and business variety) are also highlighted. Saturn tests perseverance, Venus –cooperation, and Mars – passion.
CAPRICORN (DEC 22 - JAN 19)
Mercury and the solar eclipse light up your career zone, so utilise your communication skills and natural charm to attract opportunities into your world. Monday’s terrific Mars/Saturn trine reminds you to be proactive and practical. Preparation is the key.
GEMINI (MAY 21 - JUNE 20)
Mercury (your patron planet) and the solar eclipse are energising your creativity and peer group zone, so it’s a wonderful week to create and socialise. An exciting new romance or friendship could be just around the corner. Monday is the best day to get things done.
LIBRA (SEP 23 - OCT 22)
With a solar eclipse in your sign, aim to be more proactive about where you are heading. Don’t just hope that things will magically change. The mid-week eclipse is the ideal time to set intentions and make wishes involving projects and goals.
AQUARIUS (JAN 20 - FEB 18)
The solar eclipse illuminates your travel and education zone, so it’s time to explore, study and experiment. Negotiation planet Venus also encourages you to compromise and hold out the olive branch of peace (especially to a stressed colleague at work).
CANCER (JUNE 21 - JULY 22)
With the solar eclipse and Mercury stimulating your domestic zone, it’s time for a new project. But there’s also a tricky Mercury/Mars square on Sunday, so slow down, otherwise you could find yourself smack bang in the middle of an argument or accident.
SCORPIO (OCT 23 - NOV 21)
Scorpions are sometimes stubborn creatures, This week Venus is visiting your sign, which highlights your desire for harmony and balance. Strive to be more adaptable, as other people won’t behave in predictable ways. Choose diplomacy over drama.
PISCES (FEB 19 - MAR 20)
The mid-week solar eclipse spotlights close partnerships, intimacy, secrets, trust issues and joint finances. With Saturn still transiting through your sign, you will make messy mistakes and experience disappointments along the way.
22 Eye makeup (7)
24 Furnace parts (7)
25 Sorcery (5)
26 Detached (5)
27 Jungle cat (5)
30 Hatchet (3)
32 Charged particle (3)
1. US actress Jessica Chastain (pictured) won a Best Actress Oscar for which 2021 film?
Complete the list by changing one letter at a time to create a new word at each step. There may be more than one answer.







2. A series of paintings featuring water lilies were produced by which impressionist painter?
3. In Australia, seltzer water is more commonly known by what name?
4. Which influential historical document was ratified on July 4, 1776?
5. Which prolific Austrian composer died at the age of 31 in 1828?
6. What two colours are on the flag of the United Nations?
7. What does wi-fi stand for?
8. The Pont Neuf is the oldest what in Paris?








9. The Australian Broadcasting Commission was founded in which year?
10. A standard piano has how many keys?































TPositioned








Thurs, 26 Sept, 6pm
Open from 5:30pm
8 Malkana Crescent, Buddina Ryan Bradeley 0418 793 670
Sat, 28 Sept, 10am
Open from 9:30am
2 Lighthouse Circuit, Bir nya Dan McNamara 0458 010 889
Tues, 10th Sept
Sold prior to auction
Thurs, 3 Oct, 11am
In Rooms, Sunshine Coast Func on Centre 19 West Terrace, Caloundra
3 Bandaroo Street, Warana Lachie Woods 0477 552 268 16 King Street, Kings Beach
Natascha Drexel-Munro 0410 081 970
Carola Drexel 0417 608 466
1/25 Arthur Street, Kings Beach
Natascha Drexel-Munro 0410 081 970
Carola Drexel 0417 608 466
40/27 Verney Street, Kings Beach
Natascha Drexel-Munro 0410 081 970
Carola Drexel 0417 608 466
52/70 Albert Street, Kings Beach
Natascha Drexel-Munro 0410 081 970
Carola Drexel 0417 608 466
2 Neill Street, Dicky Beach
Andrew Garland 0403 851 777
5 Coochin Street, Dicky Beach
Andrew Garland 0403 851 777
79 Corona on Avenue, Golden Beach
Tom Garland 0412 161 123
You are welcome to a end our open homes or please call the agent to arrange your private inspec on or virtual tour.
ALEXANDRA HEADLAND
3/174 Alexandra Parade2 bed 2 bath 2 car Brent Higgins 0414 775 133
29/174 Alexandra Parade2 bed 2 bath 1 car Brent Higgins 0414 775 133 BANYA
79 Cocos Crescent 4 bed 2 bath 2 car Sat 11-11:30am BIRTINYA
18 Pangali Circuit 4 bed 3 bath 2 carJacob Hussey 0416 100 509
1205/2 Bright Place 1 bed 1 bath 1 car Jus n Wijaya 0479 135 990
76A Willis Road Land: 2,004m2 Cameron Hackenberg 0421 504 479
65 Atkinson Road 4 bed 2 bath 2 carCameron Hackenberg 0421 504 479
183/171-203 David Low Way 3 bed 1 bath 1 carCameron Hackenberg 0421 504 479
35 Ginger Bell Avenue 4 bed 2 bath 2 carRachel Meyers 0411 699 619 46 Dauntless Avenue 4 bed 2 bath 2 carCameron Hackenberg 0421 504 479
19 Willis Road 3 bed 2 bathRachel Meyers 0411 699 619 46 Clearwater Circuit 4 bed 2 bath 2 carRachel Meyers 0411 699 619 34 Cu ers Way 4 bed 2 bath 2 carRachel Meyers 0411 699 619 22 Butcherbird Crescent4 bed 2 bath 4 carAlex Dale 0414 516 003
81 Cu ers Way 4 bed 2 bath 2 carCameron Hackenberg 0421 504 479
19 Philbrook Street 4 bed 2 bath 3 carCameron Hackenberg 0421 504 479
16 Grebe Crescent 4 bed 2 bath 4 carRachel Meyers 0411 699 619 BOKARINA
202/21 Kombi Street 3 bed 2 bath 2 car Jus n Wijaya 0479 135 990 BUDDINA
2/2 Point Cartwright Drive4 bed 3 bath 2 car Brent Higgins 0414 775 133 BUDERIM
11 John Lesslie Court 3 bed 2 bath 2 carThurs 26th 4-4:30pm
5 Bairnsdale Street West 3 bed 2 bath 3 car Sat 9-9:30am
11 John Lesslie Court 3 bed 2 bath 2 car Sat 10-10:30am
2/2B Centreview Court3 bed 2 bath 1 car Sat 10-10:30am
7/128-130 King Street 2 bed 1 bath 2 car Sat 11-11:30am 17 Orme Road Land: 800 sqm Sat 11-11:30am 288 Mooloolaba Road 4 bed 2 bath 5 car Sat 11-11:30am 27 Jones Road 4 bed 3 bath 2 car Sat 11-11:30am 22 Possumwood Place 5 bed 3 bath 2 car Sat 12-12:30pm
2/2B Centreview Court3 bed 2 bath 1 car Sat 2-2:30pm
2/2B Centreview Court3 bed 2 bath 1 car Wed 2nd Oct 5-5:30pm
6 Icarus Court 5 bed 2 bath 2 carTully Thompson 0428 959 238 107 Karawatha Street 5 bed 2 bath 2 carWill Van den Dungen 0438 130 188 BURNSIDE
6 Honeybee Lane 4 bed 2 bath 2 carHayley Anderson 0408 683 883 CALOUNDRA
8/7A Esplanade Bulcock Beach2 bed 2 bath 1 car Natascha Drexel-Munro 0410 081 970 CHEVALLUM
25 Glenn Vista Place 5 bed 6 bath 8 car Brent Higgins 0414 775 133 COES CREEK
54 Kundart Street 4 bed 2 bath 4 carHayley Anderson 0408 683 883 COTTON TREE
1/15 Fi h Avenue 2 bed 1.5
14 Hutchinsons Road 4 bed 3 bath 3 carKathryn Willshire 0437 434 648 KINGS BEACH
52/70 Albert Street 3 bed 2 bath 1 carNatascha Drexel-Munro 0410 081 970
8 Upper Gay Terrace 5 bed 2 bath 5 carNatascha Drexel-Munro 0410 081 970
6/18 Queen Street 2 bed 2 bath 1 carNatascha Drexel-Munro 0410 081 970 16 King Street 4 bed 4 bath 5 carNatascha Drexel-Munro 0410 081 970
40/27 Verney Street 3 bed 2 bath 2 carNatascha Drexel-Munro 0410 081 970 1/25 Arthur Street 2 bed 2 bath 1 carNatascha Drexel-Munro 0410 081 970
1 carNatascha Drexel-Munro 0410 081 970
1
6/1 Saltair Street 2
2/44 Victoria Terrace
1 carNatascha Drexel-Munro 0410 081 970 7/28 Orvieto Terrace 2 bed 2 bath 1 carNatascha Drexel-Munro 0410 081 970
MAROOCHY RIVER
580 Yandina Bli Bli Road3 bed 1 bath Ed Hackenberg 0499 199 360
MAROOCHYDORE
12 Sunpointe Street 4 bed 2 bath 2 car Sat








































Beau ful beach home located in the desirable ‘Golden Triangle’ of Dicky Beach, available for the first me in 40 years. Offering a once-in-alife me opportunity for prime loca on and lifestyle. To be sold at auc on.
• 582m² allotment, just 100 metres from the beach
• Open-plan living with high ceilings, large windows, ample natural light
• Spo ed gum mber floors for added quality, pa o with beach views
• Large deck with a NE aspect, perfect for summer breezes & winter sun
• Close to Surf Club, patrolled & pet-friendly beaches, shops & cafés
Auc on In Rooms, Sunshine Coast Func on Centre 19 West Terrace, Caloundra Thurs, 3 Oct at 11am View Fri & Sat 12-12:30pm




Loca on, views, and unsurpassed tailoring are paramount when inves ng in the highly sought-a er Kings Beach community. This residence is an ode to just that, epitomising the relaxed coastal lifestyle supported by high-end globally sourced custom-selected finishings.
• North facing, architecturally designed masterpiece with ocean views
• There are two separate garage entrances to house 5 vehicles
• Guest wing with a kitchen, lounge & dining area, laundry, brm & ens.
• To be sold on or before Auc on
Auc on In Rooms
Sunshine Coast Func on Centre 19 West Terrace, Kings Beach Thurs, 3 Oct at 11am
View Fri & Sat 12-12:30pm




28 Mountain Top Court, Mons
Where Spanish whispers blend with contemporary style. Set on a deligh ully private 2000m2 block, this grand residence is a landmark property in one of Buderim/Mons most pres gious locales.
• 5 general bedrooms & separate guest accommoda on
• Cinema, teen retreat & execu ve study
• Opulent living areas with seamless indoor outdoor flow
• Expansive alfresco area & sparkling inground pool
• A combina on of luxury and liveability


• New inground pool
• New kitchen with modern appliances
• Separate living areas
• Master suite with ensuite
• Air condi oning
• Double lock-up garage





Nestled within Australia’s fastest-growing hospital precinct, surrounded by a serene neighborhood, this property offers excep onal versa lity for residents of all walks of life. Upon entering, you’ll discover a beau fully appointed interior boas ng four spacious bedrooms and three and a half modern bathrooms. The open-plan living area is perfectly suited for relaxa on and entertainment, featuring the added convenience of a ground-floor bedroom with a private ensuite.



2/2B Centreview Court, Buderim
Luxurious Pres ge Unit with Private Li , Excep onal Finishes, and Panoramic Views
• Luxurious unit with private pres ge li
• High-end finishes including stone countertops and terrazzo les
• Master suite with large ensuite, walk-in robe, and private balcony with panoramic views
• Large windows and doors allow natural light and seamless indoor-outdoor flow
• Three outdoor area: courtyard, balcony with southern views, and private master balcony
WHY WAIT?
Ray White Buderim | 07 5445 6088

5 Coochin Street, Moffat Beach
Auc on On site Sat, 12 Oct, 10am
View Sat, 28 Sept, 10-10:30am Sat, 28 Sept, 2-2:30pm



4 2 2
The home has been beau fully renovated and offers amazing versa lity over two levels making it the perfect family home. Its proximity to the beach and easy-care gardens makes it the ideal beach home or lock-up beach house.
• Family home on a level 653m² corner allotment just metres from Dicky Beach
• Open plan living spaces complimented by polished mber floors
• Short stroll to the Ann Street surf break and dog-friendly Ballinger Beach
• If loca on and lifestyle are important to you, then do not let this rare opportunity pass you by
WHY WAIT?
Ray White Caloundra | 07 5491 5055
Auc on In rooms
Sunshine Coast Func on Centre 19 West Terrace, Caloundra Thurs, 3 Oct at 11am
View Fri & Sat 1-1:30pm
Garland 0403 851 777
Lane 0412 515 545



2/8-10 Wharf Street, Maroochydore
• Full-floor apartment in a complex of only six
• Light-filled interiors & breathtaking water views
• Mul ple living areas offering func onal living
• Spacious master with ensuite & walk-in robe
• Sun-drenched balcony, perfect for entertaining
• Short walk to shops & Ocean Street dining precinct
Ray White Maroochydore | 07 5443 2000



20/85 Picnic Point Esplanade, Maroochydore
• Private waterfront apartment with sweeping views
• Expansive living zone & spacious balcony
• Spacious master suite with spa overlooking Mount Coolum
• Northern corner apartment with no neighbours to one side
• Op mized floor plan to enjoy natural light & breezes
• Complex ameni es include pool, gym and pontoon access


















Offered to the market for the first time in 40 years, move quickly to secure this beautiful beach home located in the highly sought after Dicky Beach ‘Golden Triangle’. Standing as testament to the bespoke design and exceptional build quality, this lovingly maintained, multi-generational beach home sits on a 582m2 allotment a short 100-metre stroll down onto the soft sands of Dicky Beach. As you crest the stairs to the upper main living level, you will be captivated by the open-plan living area. The spotted gum timber floors are a nod to the quality of this home and add to the richness of the experience. If location and lifestyle are important to you, then do not let this once in a lifetime opportunity pass you by.
5 bed, 2 bath, 2 car
Auction, In Rooms, Sunshine Coast Function Centre, 19 West Terrace, Caloundra, Thursday, October 3, at 11am
Ray White Caloundra 5491 5055
Andrew Garland 0403 851 777




A beautifully presented coastal sanctuary in the heart of Wurtulla, perfectly situated between the pristine Wurtulla Beach and Lake Kawana, with the Sunshine Coast medical precinct a short distance away. This home offers the ideal blend of modern style, space and convenience, with everything you need for relaxed coastal living. As you step inside, you’re greeted by an expansive, light-filled living area downstairs. The expansive tiled space provides ample room for both living and dining. The open-plan layout seamlessly flows into the gourmet kitchen, which adjoins the undercover outdoor dining area. The pool is the highlight of the outdoor space, creating a serene backdrop to the covered alfresco patio.

2 CHINE PLACE, WURTULLA
4 bed, 2 bath, 2 car
Auction onsite Friday, October 4, at 10am
Adams & Jones Property
Karen Jones 0405 122 526





•
•
•






• Coveted waterfront location, exceptional coastal lifestyle
• Recently enhanced high specification entertaining and living spaces
• Beautiful contemporary residence - nothing to do but move-in
• Glistening in-ground pool, 10mtr pontoon
• A/C, 15kwh solar, 25kw battery & 2 EV chargers
• Cul-de-sac position and gated driveway privacy
• Close to Kawana shopping centre, Beaches

Price: Contact Agent
OPEN HOME
Saturday 28th Sept @ 10-10.30am





Tranquil Wurtulla Oasis - your coastal dream awaits!
• Contemporary coastal sanctuary - move in ready
• Multiple indoor and outdoor living spaces
• Glistening in-ground heated swimming pool
• Excellent separation of living
• Air-conditioning throughout, Solar electricity - 5kwh (approx)
• Cul-de-sac position and gated driveway privacy
• Close to beaches, shops, schools & more Auction Friday 4th Oct @ 10am

28th Sept @ 1-1.30pm
2nd Oct @ 5-5.30pm






44 Carwoola Crescent, Mooloolaba STUNNING MODERN LOW SET HOME IN MOOLOOLABA’S MOST SOUGHT-AFTER STREET!
This sophisticated single-story home embraces a low maintenance riverfront lifestyle. After extensive renovations, this impeccable home is being presented to the market in near new condition. The home offers open plan living with a floor to ceiling glass back drop framing the stunning waterways of the serene Mooloolah River. The cathedral ceilings and multiple Velux windows allow natural light to filter through, showcasing the design of this home. The chic kitchen presents with stylish marble benchtops and Miele appliances.
The quality of this home continues into the elegant master bedroom where a transparent picture window allows you to wake up with scenic water views. A design bonus of this property is the completely self-contained 1-bedroom studio. Externally this property is exquisite with a fully tiled heated pool, Accoya timber decking and refined landscaped gardens. With views out to the river, the large pontoon with black pylons which will allow almost any vessel to sit safely on your back doorstep, living here will be a breeze.

•
•
•








This multi-award winning ‘British Colonial’ masterpiece is truly breathtaking. Every detail has been carefully considered, resulting in an elegant home which delivers an abundance of space and grandeur while offering panoramic water views from almost every room. With ample living and multiple spaces, this is a beautiful family home. Properties of this magnitude and grandeur, combined with island living, are extremely rare and we urge you to inspect this property before it is gone!
• Award-winning build
• 833m2 (approx.) under roof
• Herringbone timber floors
• 18kW solar panels
• Community tennis court
• CCTV system
Price: Offers Over $4.95M Should Enquire
Inspect: Saturday 28th September 11-11:30am
Richard Scrivener 0416 799 188 Loren Wimhurst 0415 380 222 554
400 777



This prestigious property, set on a sprawling 1,100m² (approx.) lot, offers the pinnacle of luxury living with its breathtaking views of majestic mountains and tranquil coastlines. As you step inside, you’re greeted by an expansive, sophisticated space where every detail speaks to impeccable craftsmanship. The 500m² layout, over two levels, combines contemporary elegance with timeless charm, creating a sanctuary of refined comfort.






• Panoramic mountain and coastal views
• Multiple living areas
• Elevated block
• Prestigious location
•









ROSEMOUNT
5 BEDS / 3 BATHS / 10 CARS
This breathtaking 6310m2 property features park-like grounds and a picturesque spring-fed dam, offering an enviable lifestyle. The 455m2 residence has a versatile floor plan, including dual occupancy options, boasting five bedrooms, three bathrooms, an office, premium kitchen, media room, and open-plan living.
INSPECT: SAT 28TH SEPTEMBER, 1:30PM

Corey Payne
0407 044 338

Bec Cvilikas
0402 486 688




BUDERIM
4 BEDS / 3 BATHS / 2 CARS
The residence has been perfectly positioned on its 635m2 block to maximise privacy, outlook, natural light, cooling sea breezes, and prized north-easterly orientation. The floor plan has also been custom-designed to facilitate dual living which could suit those looking to house extended family members.
INSPECT: SAT 28th SEPTEMBER, 9:30AM

Corey Payne
0407 044 338

Bec Cvilikas
0402 486 688






4 BEDS / 3 BATHS / 2 CARS / STUDY







Unwanted Prize Home ... Perfectly positioned to maximise elevation, natural light, sea breezes, and sweeping ocean views; this stunning fully-furnished designer residence is the epitome of luxury coastal living. Nothing left to do except unlock, uncork (the champagne) and unwind!
AUCTION: FRI 18TH OCTOBER, 12PM ONSITE
INSPECT: SAT 28TH SEPT, 10AM & WED 2ND OCT, 5PM




1/36 Mayfield Street Alexandra Headland
FANTASTIC FAMILY HOME IN THE GOLDEN TRIANGLE AUCTION
Discover a new level of luxury and coastal living in this extraordinary residence, ideally located just 350 metres from the pristine shores of Alexandra Headland in the prestigious Golden Triangle. Spread across three meticulously designed levels, this residence offers 452 square metres of luxurious living space, making it perfect for families or those who love to entertain. As you step inside, the soaring high ceilings and expansive open-plan layout create an immediate sense of space and light, all framed by breathtaking views of the Pacific Ocean. Offering a master retreat with a private balcony, blackbutt timber spiral staircase, an internal lift, fully ducted air conditioning and a comprehensive security system, this home ticks all the boxes. 479m² 4 3 4
On Site Saturday 12th October at 9:00am VIEWING Saturday 28th September 1:00-1:30pm

RARE RIVERFRONT OPPORTUNITY - PRIME DEEP WATER LOCATION!
Positioned in one of the most prestigious riverfront locations on the Sunshine Coast, 30 Carwoola Crescent, Mooloolaba offers a once-in-a-lifetime opportunity. With its breathtaking east-facing aspect, this property showcases expansive, uninterrupted river views that capture the stunning outlook toward Mooloolaba. It stands as one of the most elite waterfront addresses, offering immense potential for those looking to create their dream home or capitalise on a redevelopment opportunity. Whether you choose to maintain the charm of the existing residence or design a new architectural masterpiece, 30 Carwoola Crescent represents a rare chance to create your ideal riverfront retreat. Properties of this calibre don’t last long. 728m² 3 2 2
AUCTION
On Site Saturday 26th October at 4:00pm VIEWING Saturday 28th September 2:00-2:30pm
The easiest way to check out Sunshine Coast auction results.
6 WHISTLER STREET, BLI BLI
SOLD UNDER THE HAMMER $940,000
4 bed, 2 bath, 4 car, pool
Ray White (Bli Bli), Alex Dale, 0414 516 003
13 DAWES DRIVE, BUDERIM
Under negotiation contact agent
4 bed, 2 bath, 2 car
Define Property Agents, Ross Cattle and Katie Davies, 0410 625 758 / 0427 268 780
1 NABILLA STREET, BUDDINA
Passed In – on market for $1,450,000
2 bed, 1 bath, 2 car
Define Property Agents, Jordan Barden, 0422 990 824
7/8-10 YALLANGA PLACE, MOOLOOLABA
Passed In – on market for $715,000, Contact agent
3 bed, 2 bath, 1 car
Define Property Agents, Ross Cattle 0410 625 758
11 KUMBADA COURT, MINYAMA
SOLD UNDER THE HAMMER FOR $2,160,000
4 bed, 2 bath, 2 car
Fletcher Riley, Alan Riley and Rebecca Fletcher, 0422 723 719 / 0404 866 358
2/31 NEERIM DRIVE, MOOLOOLABA
Passed In, contact agent
4 bed, 4 bath, 2 car, pool
Fletcher Riley, Alan Riley and Rebecca Fletcher, 0422 723 719 / 0404 866 358
14 LIGHTHOUSE CIRCUIT, BIRTINYA
Passed in, now on the market for $1,625,000
3 bed, 2 bath, 2 car, pool
Ray White (Kawana), Dan McNamara, 0458 010 889
202/21 KOMBI STREET, BOKARINA
Passed in at $1,700,000 – contact agent
3 bed, 2 bath, 2 car
Ray White (Mooloolaba), Justin Wijaya, 0479 135 990
Properties recently sold on the Coast:
9/7 BOX STREET, BUDERIM
$765,000 / 2 bed, 2 bath, 2 car
Grant Smith
3/4 COROWA COURT, MOOLOOLABA
$580,000 / 2 bed, 1 bath, 1 car
Next Property Group, Richard Scrivener & Brendan Hogan
6/10-12 MILL LANE, NAMBOUR
$490,000 / 2 bed, 2 bath, 1 car
Grant Smith
3/10 BOX STREET, BUDERIM
$850,000 / 3 bed, 2 bath, 2 car
Grant Smith
7 LIGHTHOUSE CIRCUIT, BIRTINYA
$1,200,000 / 4 bed, 2 bath, 2 car
Next Property Group, Courtney Paterson
2 HARBOUR PARADE, BUDDINA
$3,800,000 / 4 bed, 2 bath, 2 car
Next Property Group, Richard Scrivener & Courtney Paterson
26 SAINT QUENTIN AVENUE, MAROOCHYDORE
$1,050,000 / 4 bed, 3 bath, 2 car
Grant Smith
153/8 STARLING STREET, BUDERIM
$512,500 / 2 bed, 1 bath, 1 car
Grant Smith
14 LOATTA COURT, BUDERIM
$1,300,000 / 4 bed, 2 bath, 2 car, 1 pool
Grant Smith
9/90 RIVER ESPLANADE, MOOLOOLABA
$1,380,000 / 3 bed, 2 bath, 1 car
Next Property Group, Carmel La Macchia
*As supplied by contributing real estate agencies
For more auction results and property stories visit sunshinecoastnews.com.au




Showcasing the epitome of coastal luxury is this fifth-floor waterfront apartment. Positioned on the northern corner of the building, you will enjoy an unparalleled sense of privacy with no neighbours to one side and sweeping riverfront and hinterland vistas stretching out before you. Featuring three bedrooms, two bathrooms and an additional powder room, this residence is designed to impress with its functionality and expansive living zones. The master suite is a spacious retreat with a spa bath in the ensuite where you can indulge in views of Mount Coolum. This apartment combines the best of waterfront living with the ultimate in comfort and style.
3






























































6.30pm Hard Quiz. (PG)
7.00 News.
7.30 Gardening Australia.
8.30 Joanna Lumley’s Spice Trail Adventure: India. (PG) Part 2 of 4.
9.20 Guy Montgomery’s Guy Mont Spelling Bee. (PG)
10.10 Shaun Micallef’s Eve Of Destruction. (PG) 6pm Seven Local News. 6.30 Seven News. 7.00 Better Homes And Gardens. 8.30 MOVIE Ladies In Black. (2018) (PG) Angourie Rice, Julia Ormond. A young woman learns about life and love. 10.45 Armchair Experts: Grand Final Special. (PG)
6.30pm Back Roads.
7.00 ABC News.
7.30 Grantchester. (PG) A hotel manager is murdered.
8.20 Vera. is injured.
9.50 Return To Paradise. (PG) A salon owner is murdered. 10.45 Miniseries: Better.
6.30pm Compass.
7.00 ABC News.
7.30 Return To Paradise. (PG)
8.30 Unforgotten. Jess struggle to focus on the case.
9.20 Miniseries: Better. Part 3 of 5. 10.15 Fisk.
10.45 Spicks And Specks. (PG) 6pm Seven News. 7.00 The Voice. (PG)
Crime Investigation Australia:
Infamous: The Predator –Leonard John Fraser.
6pm 9News. 7.00 Rugby League. NRL. First
9.45 NRL Finals Footy Post-Match. 10.30 MOVIE Sudden Impact. (1983) investigates a series of murders.
Autopsy USA. 6pm 9News Sunday.
The Block. (PG) 8.30 60 Minutes. Current affairs program. 9.30 9News Late. 10.00 See No Evil: Alaska Serial Killer. 11.00 The First 48. 11.50 Transplant.
Deal Or No Deal.
The Project.
Sort Your Life Out. (PG) 8.45 Have You Been Paying Attention? Tom Gleisner. 9.45 The Graham Norton Show. (PG) 10.45 News. 11.10 The Project. 6pm Mastermind Australia. 6.30 SBS World News. 7.35 My Grandparents’ War: Emeli Sandé. (PG) Part 3 of 4.
The Sunday Project. 7.00 The Amazing Race Australia: Celebrity Edition. 8.30 FBI. group resurfaces. 10.30 NCIS. 11.30 The Sunday Project.
6.30pm News.
7.30 The Ottoman Empire By Train. 8.25 Sagrada Familia: Gaudi’s Challenge.
9.25 Ancient Superstructures: Istanbul’s Hagia Sophia.
10.30 Dinosaur With Stephen Fry. (PG)
6.30pm Hard Quiz. (PG) 7.00 News.
(PG) 9.35 The Assembly. (PG)
7pm News.
7.30 7.30.
8.00 Back Roads.
8.30 Take 5 With Zan Rowe: Dannii Minogue.
9.05 Louis Theroux Interviews... Anthony Joshua.
9.50 Anh’s Brush With Fame. (PG)
7pm News.
7.30 7.30.
8.00 Shaun Micallef’s Eve Of Destruction. (PG)
8.40 Guy Montgomery’s Guy Mont Spelling Bee. (PG) Presented by
9.30 Planet America.
10.00 Would I Lie To You? (PG)
6.30pm Hard Quiz. (PG)
7.00 News.
7.30 7.30.
8.00 Foreign Correspondent.
8.30 Return To Paradise. (PG) A radical eco-activist is murdered.
George Clarke’s Amazing Spaces.
Home And Away. (PG)
My Kitchen Rules. (PG) 9.15 Alert: Missing Persons Unit. goes missing. 10.15 Made In Bondi.
6pm Seven Local News.
News.
Home And Away. (PG)
The 1% Club UK. (PG)
9News.
A Current Affair.
The Block. (PG)
The Hundred With Andy Lee.
True Story With Hamish & Andy: Phil. (PG) 10.40 9News Late. 11.10 Chicago Med.
Australia’s Most Dangerous Prisoners. behind bars. 9.30 Ambulance: Code Red. 10.30 The Latest: Seven News. 6pm 9News.
RPA: Elio’s Broken Heart. (PG)
is on his last shift.
A+E After Dark.
The Equalizer.
9News Late.
NCIS.
7.30 Shaun Micallef’s Origin Odyssey.
8.30 Insight. Presented by Kumi Taguchi.
9.30 Dateline.
10.00 SBS World News Late. 10.30 The Point: Road Trip.
The Project. 6pm Mastermind Aust. (PG) 6.30 News.
(PG)
Deal Or No Deal. 6.30 The Project. 7.30 Dogs Behaving (Very) Badly Australia. (PG) 8.30 Gogglebox Australia.
to live apart.
10.30 SBS World News Late.
SBS News.


ABC PLUS (CH22) 7TWO (CH72) 7MATE (CH74) 9GO! (CH82) 9GEM (CH81)
7.30pm Children’s Programs. 8.00 Scooby-Doo And Guess Who? 8.30 Mythbusters “There’s Your Problem!”. 8.55 Robot Wars. 9.55 Doctor Who. 10.45 Children’s Programs.
7.30pm The Crystal Maze. 8.15 MOVIE The Pirates! Band Of 9.45 Amazing. 10.15 Dragon Ball Super. 10.35 Children’s Programs.
7.30pm MOVIE Early Man. (2018) (PG) Eddie Redmayne. 8.55 Fresh Off The Boat. (PG) 9.35 Speechless. 10.00 Speechless. (PG) 10.20 Doctor Who. (PG) 11.10 Inside The Sydney Opera House.
7.35pm The Inbestigators. 7.50 Operation Ouch! 8.25 Matilda And The Ramsay Bunch. 9.00 Poh’s Kitchen. 9.55 Doctor Who. 10.45 Children’s Programs.
7.35pm The Inbestigators. 7.50 Operation Ouch! 8.25 Deadly Dinosaurs. 8.55 Ice Age. 9.40 Doctor Who. 10.30 Children’s Programs. 11.15 Fresh Off The Boat.
7.35pm The Inbestigators. 7.50 Operation Ouch! 8.25 Doctor Who. (PG) 10.00 Merlin. 10.45 Fresh Off The Boat. 11.05 Speechless. 11.25 Children’s Programs.
7.35pm The Inbestigators. 7.50 Operation Ouch! 8.25 The Wonderful World Of Puppies. 9.10 72 Cutest Animals. 9.40 Doctor Who. 10.40 Children’s Programs.
6.30pm Bargain Hunt. 7.30 Chris Tarrant’s Extreme Railway Journeys. (PG) 8.30 Escape To The Country. 10.30 I Escaped To The Country. 11.30 Secrets Of Beautiful Gardens.
6pm Heathrow. (PG) 6.30 The Highland Vet. (PG) 7.30 The Yorkshire Vet. (PG) 8.30 Escape To The Country. 11.30 The Yorkshire Vet. (PG)
6pm Greatest Escapes To The Country. 6.45 Escape To The Country. 7.45 Mrs Brown’s Boys. (M) 8.30 Endeavour. (M) 10.30 Great Scenic Railway Journeys.
6.30pm Bargain Hunt. 7.30 Doc Martin. (PG) 8.30 Inspector Morse. (M) 10.50 Heathrow. (PG) 11.50 Doc Martin. (PG)
6.30pm Bargain Hunt. 7.30 Call The Midwife. (M) 8.45 A Touch Of Frost. (M) 10.55 World’s Most Scenic Railway Journeys. (PG) 11.55 Bargain Hunt.
6.30pm Bargain Hunt. 7.30 Heartbeat. (PG) 8.45 The Inspector Lynley Mysteries. (M) 10.45 Law & Order: UK. (M) 11.45 Bargain Hunt.
6.30pm Bargain Hunt. 7.30 Father Brown. (M) 8.30 Grace. (M) 10.30 Murdoch Mysteries. (M) 11.30 Father Brown. (M)
6.30pm Pawn Stars. (PG) 7.00 Football. AFL Women’s. Week 5. Western Bulldogs v Sydney. 9.15 Armchair Experts. 10.15 MOVIE Battleship. (2012) (M) Taylor Kitsch.
6pm AFL Grand Final Post-Match Show. 7.00 Storage Wars. (PG) 7.30 MOVIE The League Of Extraordinary Gentlemen. (2003) (M) 9.45 MOVIE Cliffhanger. (1993) (M)
6pm Border Security: Int. (PG) 6.30 Border Security: America’s Front Line. (PG) 7.00 Border Security. (PG) 8.30 MOVIE The Rock. (1996) (MA15+) 11.20 MOVIE Flash Gordon. (1980) (M)
6.30pm Pawn Stars. (PG) 7.30 Aussie Gold Hunters. (PG) 8.30 Outback Crystal Hunters. (PG) 9.30 Bamazon. 10.30 Jade Fever. 11.30 Mountain Men. 12.30am American Restoration.
6.30pm Pawn Stars. (PG) 7.30 Outback Truckers. (M) 8.30 Outback Truckers. (PG) 9.30 Big Rig Bounty Hunters. (M) 10.30 Deadliest Roads. (M) 12.30am American Restoration. (PG)
7pm Football. AFL Women’s. Week 6. Essendon v Sydney. 9.15 World’s Wildest Police Videos. (M) 11.15 Police Custody USA. (M) 12.15am Swamp People.
6.30pm Pawn Stars. (PG) 7.30 Air Crash Investigations: The Accident Files. 8.30 Disasters At Sea. 9.30 The Mightiest. 10.30 Mighty Trains. (PG) 12.30am American Pickers. (PG)

6pm The Nanny. (PG) 7.00 Young Sheldon. (PG) 7.30 MOVIE The Hunger Games: Catching Fire. (2013) (M) Jennifer Lawrence. 10.30 MOVIE Bad Neighbours 2. (2016) (MA15+)
7.30pm MOVIE Batman Begins. (2005) (M) Christian Bale, Michael Caine, Liam Neeson. 10.15 MOVIE Species. (1995) (MA15+) Natasha Henstridge, Ben Kingsley.
7.30pm MOVIE Man Of Steel. (2013) (M) Henry Cavill, Amy Adams, Russell Crowe. 10.15 MOVIE The Rhythm Section. (2020) (MA15+) Blake Lively, Jude Law, Richard Brake.
6pm The Nanny. (PG) 7.00 Young Sheldon. (PG) 7.30 Seinfeld. (PG) 8.30 MOVIE Rush Hour. (1998) (M) Jackie Chan, Chris Tucker, Tom Wilkinson. 10.30 Seinfeld. (PG) 11.30 The O.C. (M)
6pm The Nanny. (PG) 7.00 Young Sheldon. (PG) 7.30 Seinfeld. (PG) 8.30 MOVIE The Fate Of The Furious. (2017) (M) Vin Diesel, Michelle Rodriguez, Charlize Theron. 11.10 Seinfeld. (PG)
6pm The Nanny. (PG) 7.00 Young Sheldon. (PG) 7.30 Seinfeld. (PG) 8.30 MOVIE Rumour Has It... (2005) (M) Jennifer Aniston, Kevin Costner. 10.30 Seinfeld. (PG) 11.30 The O.C. (M)
6pm The Nanny. (PG) 7.00 Young Sheldon. (PG) 7.30 Survivor 47. (PG) 9.00 MOVIE Amsterdam. (2022) (MA15+) Margot Robbie, Christian Bale. 11.35 The O.C. (M)
5.30pm Yorkshire Auction House. 6.30pm Antiques Roadshow. 7.30 Country House Hunters Australia. 8.30 MOVIE Inside Man. (2006) (MA15+) 11.00 Surviving A Serial Killer.
6.50pm Test Rugby: New Zealand V Wallabies Post-Match. 7.15 M*A*S*H. 7.45 MOVIE Ben-Hur. (2016) (M) 10.10 MOVIE Walking Tall. (2004) (M) 11.45 MOVIE Bad Boys. (1983) (MA15+)
4pm MOVIE What Did You Do In The War, Daddy? (1966) (PG) 6.30pm M*A*S*H. (PG) 8.30 MOVIE The Best Exotic Marigold Hotel. (2011) (M) Judi Dench. 11.00 Chicago Med. (MA15+)
5.30pm Yorkshire Auction House. 6.30pm Antiques Roadshow. 7.30 Death In Paradise. 8.40 Good Karma Hospital. 9.40 Law & Order: Organized Crime.
5.30pm Yorkshire Auction House. 6.30pm Antiques Roadshow. 7.30 New Tricks. 8.40 Shakespeare And Hathaway. (PG) 9.40 Silent Witness. 10.50 To Be Advised.
5.30pm Yorkshire Auction House. 6.30pm Antiques Roadshow. 7.30 As Time Goes By. 8.40 Midsomer Murders. (PG) 10.40 Queens Of Mystery. 11.40 Killer At The Crime Scene.
6.30pm Antiques Roadshow. 7.30 Keeping Up Appearances. 8.40 Poirot. 10.50 Agatha Christie’s Ordeal By Innocence. 11.50 Days Of Our Lives.

(CH53) PEACH (CH52)
6.30pm JAG. (PG) 7.30 NCIS. (M) 9.25 NCIS: Los Angeles. (M) 11.15 SEAL Team. (M)
6pm Frasier. 6.30 Friends. 8.00 Big Bang. (M) 8.30 Thank God You’re Here. (M) 9.30 Two And A Half Men. (PG) 10.30 Two And A Half Men. 11.00 Rules Of Engagement.

6.30pm JAG. (PG) 7.30 NCIS. (M) 9.30 Bull. (M) 11.30 Bull. (PG)
6.30pm JAG. (PG) 7.30 NCIS. (M) 10.30 Bull. (M)
6pm The Big Bang Theory. (PG) 7.30 The Big Bang Theory. (M) 8.00 The Big Bang Theory. (PG) 9.00 The Big Bang Theory. (M) 10.30 Rhys Darby: Mystic Time Bird. (MA15+)
6pm The Big Bang Theory. (PG) 7.30 The Big Bang Theory. (M) 8.30 Two And A Half Men. (PG) 10.30 Two And A Half Men. (M) 11.00 South Park. (M)
6.30pm JAG. (PG) 7.30 NCIS. (M) 9.25 NCIS: Los Angeles. (M) 11.15 Evil. (MA15+) 6pm Frasier. 6.30 Neighbours. 7.00 Friends. 8.00 Big Bang. (PG) 9.30 Two And A Half Men. (M) 10.30 Two And A Half Men. 11.00 Rules Of Engagement.
6.30pm JAG. (PG) 7.30 NCIS. (M) 9.25 NCIS: Los Angeles. (M) 11.15 Evil. (M)
6pm Frasier. 6.30 Neighbours. 7.00 Friends. 8.00 Big Bang. (PG) 8.30 Big Bang. (M) 9.30 Two And A Half Men. (PG) 10.30 Two And A Half Men. 11.00 Rules Of Engagement.
6.30pm JAG. (PG) 7.30 NCIS. (M) 9.25 NCIS: Los Angeles. (M) 11.15 Evil. (MA15+)
6pm Frasier. (PG) 6.30 Neighbours. (PG) 7.00 Friends. (PG) 8.00 Big Bang. (PG) 9.30 Two And A Half Men. (PG) 10.00 Two And A Half Men. (M) 11.00 Rules Of Engagement. 11.30 Impractical Jokers.
6.30pm JAG. (PG) 7.30 NCIS. (M) 9.25 NCIS: Los Angeles. (M) 11.15 Evil. (M)
6pm Frasier. 6.30 Neighbours. 7.00 Friends. 8.00 Big Bang. (M) 9.00 Big Bang. (PG) 9.30 Two And A Half Men. (PG) 10.30 Two And A Half Men. 11.00 Rules Of Engagement.

Well, the surf has been horrible, but the whales have been amazing. This week, I had two mothers and calves come up beside me on my stand-up paddle board.
I could hear the mothers talking to the calves from above the water. I wonder what lessons they were giving them? Always take a deep breath if you are doing a deep dive, never wave to strangers, and the important one, never swim behind your father after he has been feasting on plankton – you will hate the taste!
No waves, enjoy the whale show.
(the “Publisher”). The contents of MWP are subject to copyright. Reproduction in whole or in part without the written permission of the Publisher is prohibited. The publication of editorial in MWP does not necessarily constitute endorsement of the views or opinions expressed by the Publisher. The Publisher does not accept responsibility for statements made by advertisers. All prices in MWP are correct as at the time of printing but are subject to change.
Refusal to publish in print and or online
The Publisher reserves the right to and may without prior notice refuse to publish; or cease to publish any advertising material in print and or online or inserted material within the publication without providing a reason.